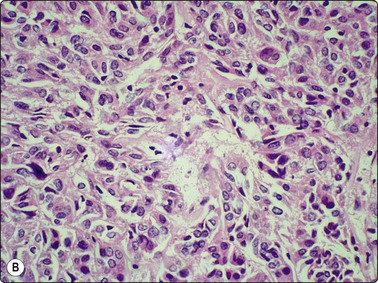
image

CHAPTER 6 Thyroid
Clinical aspects
In the past five or six decades, fine needle aspiration (FNA) cytology of the thyroid has been increasingly utilized for the investigation of thyroid lesions.1-5 The prevalence of thyroid nodules is 4–8% in Western populations.6 Since cancer is more common in solitary cold nodules, they are conventionally viewed with suspicion. While most thyroid cancers are cold on scintiscanning, the converse is not true. The prevalence of malignancy in solitary cold nodules ranges from 10% to 44.7%.7 Besides, non-palpable thyroid nodules are being increasingly detected by scanning techniques.8 Preoperative distinction of benign lesions is of paramount importance to avoid unnecessary surgery. Simplicity, diagnostic accuracy and most of all cost effectiveness4,9,10 have given FNA the status of the first-line diagnostic test in the preoperative evaluation of thyroid lesions. With increasing experience, FNA has been shown to be able to categorise many benign and malignant lesions and thereby guide therapeutic protocols. It is also useful in the diagnosis and monitoring of autoimmune thyroid lesions, especially in clinically equivocal cases and cases where biochemical and immunological parameters are normal or marginally abnormal.
The main indications of FNA in thyroid lesions are the following:
FNA has been shown to be the safest and most accurate of diagnostic tools in thyroid lesions11,12 with a sensitivity as high as 93.4%, a positive predictive value of malignancy of 98.6%, and a specificity of 74.9%; its use has simultaneously diminished the number of surgeries done for benign lesions and increased the proportion of malignancies in surgically resected thyroids. Cytological reports can and have been used to plan definitive surgery, although some surgeons still demand frozen section or paraffin-section confirmation to overcome cytological error. Frozen section has little to offer over cytology in the assessment of follicular neoplasms (FNs), as these require extensive sampling to identify capsular and/or vascular invasion. Imprints during frozen section could be very useful in the identification of follicular variant of papillary carcinoma (FV-PC)13 as the characteristic nuclear morphology is brought out to advantage in cytologic smears and is easier to identify than in frozen sections.
The accuracy of FNA is distinctly higher in centers where not only the interpretation but the needling too is carried out by the pathologist.12 Ultrasonography (US), thyroid function tests, antibody profiles and FNA, used in conjunction in selected cases, complement one another. US-guided FNA of thyroid is useful, especially in cystic and multinodular lesions harboring malignancy.14 Its value in clinically impalpable nodules has been questioned (see Chapter 2 and 3) due to the insignificant percentage of cancers in this setting.15 Recent guidelines recommending US examination in patients with palpable nodules16 have led to an emerging trend in US-guided FNA. Published data indicate reduced non-diagnostic and false-negative rates with US evaluation and US guidance.17,18
Several studies have compared the accuracy and complications of core needle biopsy with that of FNA19 that has increased adequacy rate but reduced sensitivity, especially for PC.20 Combination of core needle biopsy with FNA increases diagnostic accuracy but the problem of distinguishing benign and malignant FNs remains. In general, safety and ease of use of FNA outweigh the slight increase in accuracy achieved by core needle biopsy.
The inability of FNA to distinguish follicular adenoma (FA) from follicular carcinoma (FC) has been debated at length21-23 and in turn has led to the use of ancillary techniques to resolve this problem. Marked reduction in the incidence of FC (from 20% of thyroid cancers to less than 2%) since the practice of iodide supplementation of food supplies22,24 has, however, shifted the focus to other follicular lesions such as cellular nodular goiter (NG) and FV-PC.12
Nomenclature used in reporting
Reporting of thyroid FNA specimens should follow a standard format that is clinically relevant in order to direct management. At the National Cancer Institute sponsored thyroid state of the science conference in Bethesda in October, 2007, consensus was reached regarding indications, pre-FNA requirements, FNA techniques, diagnostic terminology, etc.25 The Bethesda System reporting terminology includes six categories: non-diagnostic, benign, atypia of undetermined origin, FN/suspicious of FN, suspicious for malignancy and malignant.26 Every category carries with it the implied risk for malignancy. Each category should be further qualified as to the possible pathological entity.
If an indeterminate diagnosis is being made due to features suspicious but not diagnostic of a neoplasm, it should be so qualified, since repeat FNA may enable definitive diagnosis. If, on the other hand, it is being made for FN, qualifying it as such will clarify that distinction of benign from malignant cannot be achieved by repeat FNA, and either ancillary techniques or histological study are required. To simplify the issue, we suggest that in the former, a diagnosis of ‘indeterminate (suspicious)’ be given and in the latter ‘indeterminate (FN)’. We suggest the revised Papanicolaou system of reporting10 which is simple and easily reproducible with the following six categories that are useful in triaging patients for either clinical follow-up or surgery:
Accuracy and limitations of cytodiagnosis
In experienced hands, and in situations where the pathologist performs the needling, cytology can be a very sensitive tool with sensitivity and specificity of up to 94% and 98% for the diagnosis of malignant lesions10 and nearly 90% accuracy rates for the identification of malignancy if follicular lesions are excluded.27,28 Cytologic diagnosis is generally accurate in thyroiditis, usual type of PC, medullary carcinoma (MC), anaplastic carcinoma (AC) and high-grade lymphoma. False negatives generally occur in cystic lesions harboring malignancy, in low-grade or intermediate-grade lymphomas occurring in a background of Hashimoto’s thyroiditis (HT), in AC with necrosis, in focal involvement of the gland by thyroiditis and in cases with dual pathology where the dominant non-neoplastic lesion overlies or obscures a small carcinoma.29-31 False negatives have been shown to be minimized by using US-guided FNA. The false-positive rate can be reduced further by excluding indeterminate follicular lesions.
Complications
There are no contraindications to thyroid FNA. Local hemorrhage may be caused by needling, occasionally causing a hematoma in the anterior neck32 that in turn may cause airway compression.33 Carotid hematoma is an extremely rare complication.34 Transient vocal cord paralysis,35 acute transient goiter,36 acute suppurative thyroiditis37 and chemical neuritis38 have been noted occasionally. Puncture of the trachea during needling usually causes coughing. Small amounts of blood may be coughed up but recovery is rapid. Needling may convert a hot nodule to a cold one and vice versa, therefore scans (and in general, all noninvasive investigations) should be done before FNA. Post-FNA infarction is an uncommon complication and most reported cases have been Hurthle cell nodules, followed by PC and FNs.39 Hemorrhage, necrosis or infarction caused by needling may occasionally obscure the histological pattern of thyroid neoplasms. Cellular and vascular granulation tissue of organising hematoma or necrosis can mimic sarcoma or angiomatous tumors. Fibrosis, papillary hyperplasia, calcification, cholesterol clefts, vascular thrombosis and capsular distortion simulating invasion are other worrisome histological alterations that occasionally follow needling.40 Changes are, in general, proportionate to the size of the needle used and the number of needle passes.41 Post-needling alterations are generally less with the fine needle capillary sampling technique41 described below. Aggressive and repeated needling and using needles thicker than 22 gauge should be avoided at all times. In cases where needling is to be repeated for inadequate or inconclusive cytology, it is wise to allow an interval of a week to 10 days for any artifacts of initial needling to minimize.42 Rare cases of tumor implantation along the needle track have been documented43-45. Use of fine-caliber needles (24 gauge or less) and gentle needling technique are stressed to avoid complications and to maximize patient comfort.
Technical considerations
After examining the thyroid with the patient sitting upright, the patient should be made to lie supine with a pillow behind the neck for hyperextension, which makes the lesion more obvious. The fine needle capillary sampling technique is eminently more suitable in vascular structures like thyroid as it provides cellular material with minimal dilution by blood. After instructing the patient to refrain from swallowing, the lesion is needled with a fine needle (gauge 25–27), quickly and gently at different angles and points of entry. Needling should be concluded before or as soon as material appears at the hub of the needle, the needle then attached to an air-filled syringe, and material deposited and smeared on to clean glass slides. Half of the smears can be air-dried for May Grünwald Giemsa (MGG) or Diff-Quik stain while the rest should be wet-fixed in ethanol for Papanicolaou (PAP) stain (that brings out nuclear details to advantage). If the aspirate is scanty, air-drying with Diff-Quik or MGG stain is better as it ensures retention of 100% of cells on the slide. Rapid smearing is important in bloody samples, as clotting of blood will entangle diagnostic cells and distort morphology. Slow drying of wet samples causes nuclear shrinkage and loss of cytological characteristics. A hair-dryer can be used for rapid drying but should be avoided in samples that may be infectious, to avoid aerosols. Despite cost and compensation issues, bedside evaluation of a Diff-Quik or ultrafast PAP-stained smear is advantageous to ascertain adequate cellularity and representative sampling and to select cases for ancillary studies.42,46,47
In cystic lesions where fluid appears at the hub of the needle, the needle should be withdrawn and FNA done using a 22-gauge needle attached to a syringe that will enable aspiration and possible evacuation of cyst contents. After evacuation, any palpable lesion remaining should be needled to minimize chances of missing a neoplasm in the cyst wall. Needling sometimes causes the cyst to fill up with blood and US-guided repeat needling can be done after resorption of blood. Surgical excision can be postponed until after repeat needling of cytologically indeterminate lesions (done after 7–10 days), which often gives a definitive diagnosis. US-guided needling improves the diagnostic yield, especially in very small nodules, retrosternal or mediastinal lesions and enlarged parathyroid glands.48,49 In all US-guided cases, pathologist and radiologist should work together with small-caliber needles, completing the procedure quickly to minimise dilution with blood and reduce chances of the sample clotting within the needle. Rapid bedside evaluation of smears is mandatory to ensure representative sampling. In situations where US-guided FNA yields hemorrhagic material and an on-site pathologist is not available, cell blocks may give better results than direct smears.50
Poor smearing technique and issues involving specimen transportation to the laboratory have led to increasing use of liquid-based processing (LBP) at some centers.8 While LBP has the advantage of enabling ancillary tests such as immunostains and molecular techniques,51 specific tumor categorization was found to be less frequent as compared to conventional smears.52 While LBP is a good option in situations where the needling and smearing are performed by a variety of personnel, the importance of training the operator in the technique of optimal smear-making cannot be overemphasized. Increasing use of LBP may also lead to diminishing skills in direct smear reading, which is required for on-site assessment. On-site assessment not only helps determine specimen adequacy but helps triage the specimen to methods that optimize its diagnostic value.8,46
Ancillary techniques
In recent years a number of immunocytochemical and molecular markers53 have been applied to cytological material from thyroid. Ethanol fixed smears, destained smears, LBP preparations or cell blocks can be used for immunocytochemistry.
Thyroglobulin, thyroid transcription factor and calcitonin help to identify cell type in less differentiated thyroid cancers. Cytokeratin 19, HBME-1 and CD44 are helpful in distinguishing PC from other thyroid carcinomas. Galectin 3 has been used to predict PC and oncocytic lesions, combination of galectin 3 and CD44v6 in distinguishing FA from FC54-56 and thyroperoxidase as a marker of benignity.57 Telomerase activity58 and microarray analysis59 have been tried as predictors of malignancy and BRAF mutation to indicate extrathyroidal extension of PC. Cyclin D1 and D3 have been used to predict malignancy in oncocytic lesions.60
Morphometric evaluation has been tried, mainly in the distinction of FA from FC, with varying results.61,62 Nucleolar measurement, numbers and area of silver-stained nucleolar organiser regions (AgNORs)63 and DNA ploidy64 are other prognostic indicators in FN. Electron microscopic studies may be useful in selected cases.
Cytological features
Unless otherwise stated, the appearances described refer to MGG/Diff-Quik stained smears.
While abundant colloid without altered blood or debris usually indicates a benign lesion, the presence of intact and well-fixed follicular cells is obligatory for a smear to be considered as satisfactory. Relaxing the criteria for a satisfactory sample often leads to higher rates of false-negative diagnoses. Many false-negative diagnoses in thyroid cytology are related to poor-quality specimens being reported as nonmalignant.65 A cytological sample from a benign thyroid nodule can be considered satisfactory if six clusters of benign cells are seen in at least two slides prepared from two needle passes.66 This criterion can be softened in situations where the pathologist performs the procedure. Two to three needle passes, performed gently and with small-caliber needles, are usually accepted easily by the patient. Increased numbers of needle passes improve the diagnostic rate but often at the cost of patient discomfort. US-guided procedures can greatly diminish non-diagnostic rates, especially when radiologist and pathologist work together.
Follicular epithelial cells and colloid are regular features in normal thyroids and in colloid goiter. Follicular cells show fragile gray-blue or pale-blue cytoplasm with indistinct or fuzzy cell borders. Coarse blue (paravacuolar) cytoplasmic granules may be seen (Fig. 6.1). Bare nuclei, similar in shape and size to normal lymphocytes, are common. Some cells may show small nucleoli.

Fig. 6.1 Follicular epithelium
Uniform cells with fragile, partially disrupted cytoplasm; bare lymphocyte-like nuclei in a background of thin colloid (MGG, HP).
In non-bloody specimens, thin colloid stains blue, violet or pink and forms a thin membrane-like coating or film, with folds and cracks due to drying of colloid on the slide (Fig. 6.2A,B). Colloid may wash off from the slide while staining but the parched-earth or crazy-pavement artifact of colloid remains and follicular cells are often seen at the smear margins. Thick colloid appears as round, dense clumps of deep blue, violet or magenta-colored acellular material, or as globular masses with superimposed follicular cells, especially in samples from NG. Colloid can be mistaken for hyalinized collagenous stroma (collagenous spherules) or amyloid. Skeletal muscle fragments appear as straps of dark-blue material with pale ovoid nuclei and cross-striations visible in higher magnification. In PAP-stained smears, thin colloid stains pale green or orange, with cracking artifacts seen. Thick colloid appears as clumps of dark green or orange material (Fig. 6.2C,D). The blue violet color and hyaline texture of colloid appear to advantage in MGG-stained smears and distinction from fibrillary collagen and deep magenta staining amyloid is easier (Fig. 6.3). In bloody smears, colloid resembles other protein-rich fluids, including serum.




(A, B) Thin colloid forms a varnish-like coat of relatively homogenous material, characteristic ‘crazy pavement’ and cracking artifacts (A, MGG IP; B, Pap, IP); (C, D) Thick colloid forms irregular dense clumps of material; homogeneous and violet in MGG; variable density and staining in Pap. Compare with Figure 6.3 A and B (C, MGG, IP; D, Pap, IP).

(A) Fragment of collagenous stroma; fibrillar texture; red staining; a few nuclei included (MGG, HP); (B) Clump of amyloid in medullary carcinoma; structureless but not homogeneously hyaline; magenta color (MGG, HP oil).
C-cells resemble medullary thyroid carcinoma cells and need immunocytochemical stains for identification, except in C-cell hyperplasia, where they are present in large numbers. Accidental puncturing of the trachea or larynx during FNA can be suspected if the patient coughs and air enters the syringe. Smears show mucus, respiratory cells and carbon-laden macrophages. Cartilage may be seen, appearing as brilliant magenta flecks with fibrillary edges.
A diffusely enlarged gland with smears showing a normal cytological appearance (or abundant or very thick colloid) indicate a simple colloid goiter which is an early stage in the evolution of NG.


Follicular epithelial cells, some of hyperplastic type with abundant fragile cytoplasm, some of involutional type with small, dark, mainly naked nuclei, background of thin colloid (A, MGG, HP; B, Pap, HP).


Cystic degeneration: involutional follicular epithelium, foamy macrophages, background of blood and thin colloid (A, MGG, HP; B, Pap, HP).


(A) Flat monolayered sheet of epithelial cells representing a flattened macrofollicle; sheet has frayed edges, honeycomb structure (Pap IP); (B) Intermediate-size follicle seen as a three-dimensional ball of cells confined by a basement membrane (MGG, HP).
Smears show abundant thick or thin colloid, follicular cells in monolayered sheets, poorly cohesive groups and as single cells, globular colloid masses with superimposed follicular cells, bare nuclei and pigment-laden histiocytes (foam cells) in varying proportions. Involutional follicular cells with small round dark nuclei and fragile, feathery cytoplasm as well as larger, hyperplastic cells with abundant vacuolated cytoplasm or with marginal vacuoles (fire-flares) are seen (see Fig 6.9). The latter may show anisonucleosis. Oxyphilic (Hurthle) cells may be seen.
Macrofollicles disrupted by needling flatten on the slide to form monolayered sheets of epithelial cells. These have a honeycomb structure due to distinct cell membranes (Fig. 6.6A)3 and frayed edges. Focally, the cytoplasm is indistinct, forming a web-like background to the nuclei. Smaller follicles may be removed intact by the needle. They appear as spherical cell clusters resembling multinucleate giant cells (Fig. 6.6B), that may be enveloped by a basement membrane. Macrofollicles are evidence of benignity and are of diagnostic significance. Hyperplastic papillae containing follicles and intact dilated follicles in cell-block preparations are supportive evidence of a benign nodule. Foam cells, often hemosiderin-laden, suggest degeneration, commonly seen in NG (Fig. 6.5A). Distinction between degenerate epithelial cells and true macrophages is not always possible as transitional forms occur that show epithelioid as well as histiocytoid features and focal atypia. Hyalinized stroma presents as irregular pink/red frayed fragments of vaguely fibrillar material, some with adherent epithelial cells (see Fig. 6.3A).
Inadequate samples may be obtained from colloid nodules due to low cellularity and degenerative change. If smears contain few or no well-preserved follicular cells, the specimen should be reported as non-diagnostic, unsatisfactory, and repeated.
The cytological appearances of NG can overlap with FN and cytological criteria alone cannot always reliably distinguish between the two. Selective sampling of a microfollicular focus in NG leads to a repetitive pattern of microfollicles or rosettes with no colloid, and distinction from FN may be impossible.67 However, since this is a focal phenomenon, samples from other areas are likely to show macrofollicles, abundant colloid and degenerative changes recognizable as colloid goiter. In the cytological spectrum of follicular nodules, a large sheet pattern of follicular cells with thin colloid in the background indicates a macrofollicular pattern suggestive of benignity while syncytial clusters with nuclear crowding and overlapping suggest a neoplasm.68
Cystic PCs often contain abundant colloid. This can cause diagnostic difficulties if smears are poor in cells, but a close look at the nuclear features should allow a correct diagnosis in most cases, as detailed below. Smears in FV-PC may show well-formed follicles containing colloid.
Groups of large cells with irregular nuclei, not infrequently found in NG, are probably related to degenerative change. Their origin is uncertain; they may be histiocytes or regenerating epithelial cells consistent with repair (Fig. 6.7). Prominent aggregates of histiocytes can in some cases mimic cells of PC due to similar nuclear features.69

Fig. 6.7 Histiocytes in nodular goiter
Histiocytes with abundant cytoplasm and enlarged, irregular nuclei with distinct nucleoli; these could be mistaken for atypical epithelial cells; bare nuclei of degenerate follicular cells in the background (MGG, HP).
The value of cytology in hyperfunctioning nodules has been disputed but recent reports suggest that there may be an increased incidence of malignancy in hyperthyroidism and that FNA is a reliable diagnostic method in these cases. It appears reasonable, therefore, to evaluate these lesions cytologically prior to radioactive iodine treatment or surgical intervention.70
Thyroid cysts are most commonly due to retrogressive changes in NG where they may be small, yielding a few drops of fluid or larger cysts yielding substantial quantities. FNA yields brownish colloid-like fluid with altered blood. Smears show foam cells that may contain hemosiderin and sparse degenerating follicular epithelium (see Fig 6.5).31,71
Cystic change and/or hemorrhage occur in thyroid tumors (25% of PCs, and 20% of FNs in one series).72 Prevalence of malignancy in resected cystic nodules is 10–15%.4,31 Partly solid and cystic nodules may also harbor malignancy.
A definitive diagnosis of cystic NG requires adequate sampling of any solid component. Cystic fluid containing only macrophages and no epithelial cells does not rule out a cystic neoplasm. The gross appearance of cyst fluid is not helpful.31 Presence of atypical cells in a ‘cyst fluid only’ sample should lead to a ‘suspicious’ diagnosis (not non-diagnostic).73 A cystic lesion that can be completely evacuated with no palpable nodule remaining and no epithelial atypia indicates benignity.71 While 4–40% of cystic lesions can be permanently cured by FNA, others need repeated evacuations. False-negative cytological diagnosis is most common in cystic carcinomas, especially PC, where only up to 60% can be correctly diagnosed.71,74 Re-biopsy of the cyst bed and of any residual or recurrent swelling, preferably with US-guidance, is advisable. Recurrent cysts, lesions greater than 3–4 cm in diameter and lesions in young males are indications for surgical excision.
Thyroglossal cysts yield clear or mucoid fluid and smears may contain squamous or respiratory epithelium associated with colloid.75 Foregut cyst of thyroid yields yellowish fluid and smears show detached ciliary tufts and macrophages.76 Rare epidermoid cysts of thyroid have been described.77
Clear fluid aspirated from a lateral cystic lesion suggests a parathyroid cyst and parathormone estimation of the fluid is advised.78 Thymic cysts yield clear fluid containing lymphocytes.
This is an uncommon but potentially life-threatening condition79 occurring mostly in debilitated or immunosuppressed individuals.42 Patients present with extremely tender thyroid enlargement, fever and high ESR. Smears show neutrophils, necrotic cells and debris. Intracellular bacteria, (usually Gram-positive cocci), may be present. Less commonly, mycobacteria, viruses, aspergillus, actinomycosis, cryptococcosis and pneumocystis have been observed.42 Cytologic material can also be sent for culture and sensitivity.
Problems and differential diagnoses
Smears in AC often show a prominent inflammatory and necrotic component with atypical histiocytoid or fibroblastoid cells. Bacteria (demonstrable by MGG or Gram stain) may be seen in thyroiditis and bizarre giant and spindle cells in AC. Other differential diagnoses of acute thyroiditis are lymphadenitis with abscess, infected thyroid cyst, granulomatous thyroiditis and phlegmonous diffuse neck inflammation that can be resolved by clinical and radiological means.
The syndromes comprising autoimmune thyroid disease are many intimately related illnesses, the two most common being Graves’ disease (GD) (with goiter, hyperthyroidism and, in many patients, associated ophthalmopathy) and Hashimoto’s thyroiditis (HT) (with goiter and euthyroidism or hypothyroidism). Immunological mechanisms in these diseases are closely related and the syndromes are connected together by similar thyroid pathology, co-occurrence in family groups, and transition from one clinical picture to another within the same individual over time. Antibodies to thyroid peroxidase (TPO-Ab), produced mainly by intrathyroidal lymphocytes, are the hallmark of autoimmune thyroid disease and are present in most patients with HT and in 75% of patients with Graves’ hyperthyroidism.80
Graves’ disease (primary hyperplasia) (Figs 6.8 and 6.9)81,82
Cytological study is not usually sought in GD as the clinical and biochemical profile are characteristic in most cases. However, cytology aids distinction from other conditions that present with thyrotoxicity, such as toxic NG, de Quervain’s thyroiditis, HT presenting in toxic phase and rarely in thyroid carcinomas.70
Smears are bloody with scant colloid. Cellularity is moderate to high with follicular epithelium present as monolayered sheets, rings or follicular structures with suggestion of columnar shape (Fig. 6.8A). Cytoplasm is abundant and cobweb-like and delicately vacuolated, with larger marginal vacuoles giving a characteristic ‘fire-flare’ appearance.82 ‘Fire-flares’ are pale pink/red clumps of material measuring 1–7 µm in diameter, often with a pale center, mainly seen at the rim of the cytoplasm around the edges of aggregates of follicular cells (Fig. 6.9). They may correspond to colloid droplets seen ultrastructurally or to dilated cisternae of endoplasmic reticulum, and are indicative of cellular hyperactivity. They are present in toxic NG, and may be seen in a smaller percentage of cells in HT, diffuse or nodular goiter, and occasionally in neoplasms, including carcinoma.83,84 In untreated GD, however, up to 100% of cells may show fire-flares. Paravacuolar granules may be seen. There may be moderate to marked nuclear atypia, especially in cases treated with radioactive iodine or neomercazole (Fig 6.8B).85 Papillary structures may be seen, occasionally resembling PC. Hurthle cells and lymphocytes and rarely multinucleate giant cells or epithelioid cells may be seen.82


(A) Clusters of hyperplastic epithelial cells with a follicular arrangement; abundant pale vacuolated cytoplasm and suggestion of columnar shape; (B) Striking anisokaryosis/nuclear atypia in a case of medically treated GD of long duration (MGG, HP).

Fig. 6.9 Marginal vacuoles/’fire flares’
Loose sheet of hyperplastic follicular cells with abundant cytoplasm and relatively large nuclei; note clumps of homogeneous pale pink material, so-called ‘fire flares’ around the periphery of the sheet; no clinical evidence of hyperthyreosis in this case (MGG, HP).
Problems and differential diagnoses
Dilution of cells by blood may result in paucicellular, non-diagnostic smears. The bloody, colloid-free, highly cellular cytological appearance in GD with nuclear atypia may be mistaken for a neoplastic lesion, especially in the absence of proper clinical details. The cytoplasm in cells of GD is very delicate and shows a cobwebby, lace-like appearance, unlike the denser cytoplasm and better-defined cell margins seen in neoplastic lesions, especially PC.
Autoimmune thyroiditis (Hashimoto’s thyroiditis/lymphocytic thyroiditis) (Figs 6.10-6.13)81,86-89


Fig. 6.10 Hashimoto’s thyroiditis
Aggregates of oxyphil cells; background of blood and lymphocytes; note abundant cytoplasm, anisokaryosis and prominent nucleoli in A, more numerous lymphoid cells in B (A, MGG, HP; B, Pap, HP).


Fig. 6.11 Hashimoto’s thyroiditis
(A) Syncytial cluster of oxyphil cells; abundant cytoplasm; prominent anisokaryosis; (Pap, HP oil); (B) Poorly cohesive hyperplastic cells showing oxyphil transformation; some resemblance to histiocytes; adherent lymphocytes (Pap, HP).


Fig. 6.12 Florid lymphocytic pattern of HT, 2 cases
(A) Polymorphous population of lymphoid cells with high lymphoid : epithelial cell ratio (follicular cells in top center, MGG, IP); (B) Cellular smears, mainly reactive lymphoid cells, cluster of follicular cells in centre (MGG, HP).

Fig. 6.13 Hashimoto’s thyroiditis
Plump epithelioid-like oxyphil or histiocytic cells forming a granuloma-like cluster (MGG, HP).
Lymphocytic thyroiditis and HT represent different phases or manifestations of an organ-specific immunologically mediated inflammatory disease. A defect in suppressor T cells makes the gland vulnerable to cytotoxic T cells and stimulates T-helper cells to induce autoantibody production.90 Patients usually present with diffuse or nodular thyroid enlargement and altered thyroid function caused by gradual immunologically mediated destruction of the gland. Antithyroid antibodies (especially microsomal/TPO-Ab) are significantly elevated in most cases. HT is one of the major manifestations of autoimmune thyroid disease, the other being GD.91 It is more common in Asians.92 In multiethnic Malaysia, a study of 88 cases of HT showed it to be more common in Indians than Chinese or Malays, and nodular presentation was seen in about one-third of cases.93
A bloody background with lymphoid cells, degenerative changes in follicular cells and infiltration of follicular cells by lymphoid cells are characteristic features of HT. Variable features include oxyphilic cells (Hurthle cells), plasma cells, epithelioid cell granulomas and multinucleated giant cells.
The ‘lymphocytic’ pattern of HT occurs in children and young adults with a shorter history of the disease and absent or low antibody titers.88 Smears are dominated by a mixed population of lymphoid cells including centroblasts, immunoblasts and dendritic reticulum cells from germinal centers characteristic of a reactive lymphoid proliferation (Fig. 6.12). Germinal center histiocytes have plentiful pale cytoplasm and oval or indented histiocytoid nuclei with granular chromatin. They are often clustered and associated with lymphoid cells, some of which lie within their cytoplasm. Histiocyte-lymphocyte rosettes or lympho-histiocytic clusters may be seen. Lymphoid : follicular cell ratios are often as high as 10 : 1 with epithelial cells so inconspicuous that smears resemble reactive lymphoid hyperplasia (Fig 6.12 A).
‘Classic’ or ‘florid’ HT occurs in older patients (usually women), who are more often hypothyroid and have raised TPO-Ab. The smear background shows lymphocytes with a variable number of plasma cells. There is prominent oxyphilic (Hurthle cell/Askanazy cell) change with single and syncytial aggregates of cells showing abundant, dense, finely granular, gray-blue cytoplasm (MGG), and well-defined cell borders. Nuclei are 2–4 times the size of normal follicular cell nuclei (Figs 6.10 and 6.11) and may show atypia and prominent nucleoli. Normal-appearing follicular cells may be present, showing features of hyperactivity. A characteristic feature is that of lymphocytes (and occasionally plasma cells) seeming to adhere to or infiltrate follicular cells, supporting the theory of direct epithelial damage by lymphocytes. Multinucleated giant cells and epithelioid cells can be seen in up to 40% of cases.87,93 Neutrophils and eosinophils may be seen adhering to or infiltrating follicular cells in early stages.42,93
Seven to thirty-three percent of cases are antibody negative.87,90,93 In a study of 150 cases of HT, overall Ab positivity was found to be 88.67%.94 TPO-Ab showed significant correlation with high lymphoid : epithelial ratios but not with cases showing follicular hyperplasia or hashitoxicosis (see below). It appears that antibody positivity may depend on the phase of the disease. Absence of serum antibodies can also be explained on the basis of local antibody production by intrathyroidal lymphocytes.93
Stripped follicular cell nuclei resemble lymphocyte nuclei in size and shape. However, they have more homogenous chromatin and denser nuclear rim and lack the basophilic rim of cytoplasm seen in lymphocytes. Smears in HT show a polymorphous population of lymphoid cells (including mature and transformed lymphocytes) with lymphoglandular bodies in the backgound.
Lymphoid cells are often seen in smears from PC, especially the diffuse sclerosing and Warthin-like variants.95,96 Multiple sampling is important to ensure representative sampling so that neoplastic cells are not missed. Histological sections from thyroids resected for NG often show focal collections of lymphoid cells or lymphoid follicles. This does not imply a diagnosis of thyroiditis and review of cytologic smears from such cases rarely show lymphoid cells.81
Some cases of HT may present in a hyperthyroid state with increased T3 and T4 levels (hashitoxicosis).87 In these cases, TPO-Ab are often negative.94 Smears are highly cellular with hyperplastic follicular cells showing fire-flares. Lymphoid and Hurthle cells may be few or focal, and distinction from GD is often difficult or impossible. Six monthly follow-up of these cases with cytological monitoring and thyroid function tests have shown the patients becoming euthyroid within a few months to 2 years, with concurrently changing smear pattern to reflect the usual features of HT.42 Awareness of the close kinship between various forms of autoimmune thyroid disease (GD, HT and postpartum thyroiditis – described later) facilitates diagnosis and management.
While high-grade non-Hodgkin’s lymphoma is easily identified on cytological preparations, low-grade and MALT lymphomas are often difficult to distinguish from reactive lymphoid populations seen in thyroiditis. Approximately 75% of lymphomas arise in a background of HT. Focal involvement can cause sampling problems. The smear pattern may be of HT in one part of the gland, that of obvious lymphoma in another (see Fig. 6.65). The ‘florid lymphocytic’ type of thyroiditis with scant epithelial cells, common in young patients, should be viewed with suspicion if found in elderly individuals, and efforts made to rule out lymphoma. Flow cytometry and molecular assessment of lymphoid infiltrates in fine needle samples are being increasingly used for the distinction of lymphoma from thyroiditis.97
Follicular and Hurthle cells in HT may show atypia significant enough to cause concern to the inexperienced observer (Fig. 6.11A). Sometimes, and more often in younger patients with florid lymphocytic thyroiditis, abundant active-looking epithelium may be aspirated, leading to a suspicion of neoplasia. While Hurthle cell atypia in a background of lymphoid cells is recognized as part of the diagnostic spectrum of the disease, selective sampling of lesions of focal nodular hyperplasia constituted by atypical Hurthle or follicular cells (seen in early phase of some cases of HT) with scanty or no lymphoid populations can be easily mistaken for neoplasia.42,87 In so-called ‘burnt-out’ HT only oxyphilic cells may be present in smears.89,98,99 This problem is more pronounced when such a case has a nodular presentation. Multiple sampling offers the best chance of finding evidence of lymphoid infiltration. Disorganized, poorly cohesive masses of oxyphilic cells with prominent nucleoli are more indicative of neoplasia, sheet-like structures infiltrated by lymphocytes of hyperplasia.100 However, this distinction is not always obvious. Some authors advise against making a diagnosis of follicular/oxyphilic neoplasm in the presence of pleomorphism and abundant lymphoid cells.82,101,102 The possibility of a neoplasm with surrounding HT should be considered if abundant epithelium and lymphocytes are aspirated.98,101,103 Coexistence of HT with differentiated thyroid carcinoma (4%) or lymphoma (1%)42 may have to be considered, especially in cases with nodular presentation, observed in 22–80% cases in various series.104,105
Many ‘hypertrophic epithelial cells’ with abundant cytoplasm are present in early stages of thyroiditis. These lack the dense cytoplasm and well-defined cytoplasmic borders of Hurthle cells. Some may even have ‘fire flares’ and presumably represent TSH-stimulated cells. Epithelioid-like cells with elongated, spindle-shaped cytoplasm and elongated or bean-shaped nuclei may be seen. These may resemble oxyphilic cells and forms morphologically intermediate between these two types occur (Fig. 6.13). Histiocytes or dendritic reticulum cells from germinal centers could be confused with oxyphilic cells, but lack the characteristic cytoplasmic density.
Cases of HT showing giant cells and/or epithleioid cells93 may be confused with granulomaotus thyroiditis (GT).81 The inflammatory infiltrate in GT is not uniformly lymphocytic but is mixed, with evidence of more severe tissue destruction. The smear pattern is dominated by multinucleated giant cells surrounding extruded colloid and epithelioid cell collections. A few cases have showed overlap in cytological features with HT,106 and thryoid function tests and antibodies are required to clarify the diagnosis.
Fibrosing variant of HT may be confused with Riedel’s struma,42 a rare thyroid manifestation of systemic collagenitis occurring in euthyroid middle-aged women. Smears yield paucicellular material containing collagenous fragments, bland or plump spindle cells and myofibroblasts.107
Psammoma bodies have been described in association with HT108 and in other benign processes. Their presence in smears probably warrants surgical biopsy because of close association with PC. Association of HT per se with PC is also reported.109
de Quervain’s thyroiditis (subacute thyroiditis; granulomatous thyroiditis) (Figs 6.14-6.17)42,81,87
This is a spontaneously remitting granulomatous inflammation of the thyroid, of possible viral etiology, occurring predominantly in females from the second to the fifth decades. Patients usually present with chills, fever, fatigue and a painful tender goiter that may be unilateral or spread from one lobe to the other.
Smears in GT are dominated by the presence of large multinucleate giant cells with numerous nuclei, granulomatous aggregates of epithelioid cells, degenerating follicular cells, neutrophils, macrophages and lymphocytes in a dirty smear background that shows debris and colloid.
The follicular cells often show degenerative features and contain dark-blue (golden in PAP-stained smears) cytoplasmic ‘paravacuolar’ granules representing lipofuscin or lysosomal debris. These granules are not a specific feature of this condition and may be seen in involutional follicular cells of NG, in GD and occasionally in PC and FNs.110 Stripped or crushed nuclei may be present. The giant cells are the hallmark of the disease and are characteristically very large, containing up to 200 nuclei (Figs 6.14 and 6.15), but even without them the diagnosis may be suggested if the other features of the disease are present (Fig. 6.16). Hurthle cells may be seen in some cases.

Fig. 6.14 de Quervain’s thyroiditis
Large multinucleated giant cells; clumps of thick, engulfed colloid (MGG, IP).

Fig. 6.15 de Quervain’s thyroiditis
Huge multinucleate histiocytic giant cells, dirty background of clumps of colloid, inflammatory cells and degenerate epithelial cells (Pap, IP).

Fig. 6.16 de Quervain’s thyroiditis
Mixed cell reaction; histiocytes, degenerating epithelial cells and lymphocytes in a ‘dirty’ background with thin colloid (MGG, HP).
The overlap with cases of HT showing multinucleate giant cells and granulomas has already been discussed. Epithelioid and giant cells may rarely be seen in GD. Giant cells are often seen in PC in association with lymphocytes and therefore PC must be considered in the differential diagnosis.111 Rarely, the thyroid may be the site of mycobacterial infection, sarcoidosis or other infectious granulomatous processes.42
Cases showing Hurthle cells may be confused with HT.106
A small follicle withdrawn intact may simulate a multinucleate giant cell. The spherical nature and distinct outline of the structure in contrast with the irregular, flat form of true histiocytic giant cells should prevent confusion (Fig. 6.17A).

Fig. 6.17 de Quervain’s thyroiditis
(A) ‘Pseudogiant cell’; a small follicle in a smear from NG with a smooth well-defined border and a small amount of colloid in the center; superficial resemblance to a multinucleated giant cell (MGG, HP oil); (B) Degenerating epithelial cells with paravacuolar granules (left) and epithelioid histiocytes (right) in de Quervain’s thyroiditis (MGG, HP).
Cases with nodular presentation may simulate a lymph node or a neoplasm. Conversely, carcinomatous involvement of thyroid can mimic GT112,113 or simulate silent thyrotoxic thyroiditis (hyperthyroiditis).
Characteristic cytological features of GT may be absent in the resolving phase of the disease.
Vigorous palpation of the gland may cause extrusion of follicular colloid, inciting a giant cell reaction. These granulomas are scanty, minute and clinical and functional profiles of GT are absent.114
Silent thyrotoxic thyroiditis (painless thyroiditis, subacute lymphocytic thyroiditis)88,115,116 usually occurs in women as a sporadic or post-partum condition (post-partum thyroiditis), presenting with a small, diffuse, painless goiter. The disease may go through hyperthyroid, euthyroid, hypothyroid and recovery phases similar to GT. Low titers of TPO Ab are transiently present in two-thirds of cases. Smears show scattered lymphoid cells and giant cells in occasional cases. Unlike GT, there is no pain or any evidence of preceding viral infection and granulomas are uncommon. Rare cases have shown cytologic similarity to HT.116
Follicular neoplasms (Figs 6.18-6.24)23,29,68,117-120


Cellular smears of single cells, microfollicles or rosettes in a repetitive manner; benign adenoma by histology (A, MGG, HP; B, Pap, HP).


Smears very similar to Figure 6.18; follicular carcinoma with vascular invasion by histology (A, MGG, HP; B, Pap, HP).


Microfollicular cell clusters/rosettes; some nuclear hyperchromasia and coarseness in both (A) follicular adenoma and (B) follicular carcinoma (MGG, HP oil).


(A) Small intact follicles with basement membrane; small uniform nuclei; follicular adenoma. (B) Microfollicular groups; enlarged nuclei; drop of abnormal colloid in small central lumen; follicular carcinoma (MGG, HP).

Fig. 6.23 Follicular carcinoma
Aspirate of distant lymph node metastasis of disseminated follicular carcinoma; syncytial cluster with some rosetting; bland nuclear chromatin; mild nuclear enlargement and anisokaryosis (MGG, HP).


Fig. 6.24 Atypical adenoma and well-differentiated follicular carcinoma
(A) Smear from atypical adenoma with bizarre cells; histology showed similar epithelial atypia but no capsular or vascular invasion; uneventful follow-up; (B) Well-differentiated follicular carcinoma metastatic to bone – cellular smear with prominent microfollicular pattern, relatively uniform nuclei and fire-flares (MGG, HP).
FNs are classified as benign (FA) and malignant (FC). FAs and most FCs are encapsulated tumors, occurring in one of the lobes. Histological diagnosis of a well-differentiated FC requires demonstration of capsular and/or vascular permeation. Most FNs, especially adenomas, have a uniform internal structure that is reflected in the cytological smears. FAs are more common in women and microscopically show a variety of histological patterns such as microfollicular (fetal), normofollicular, macrofollicular, trabecular, solid (embryonal), Hurthle cell and atypical adenomas.42 Cytologically, follicular lesions include FA, FC, cellular NG and FV-PC.121
Smears in FN are cellular in a bloody background that is usually devoid of colloid. Many uniform-sized follicular cell clusters, microfollicles and rosette formations are present. Syncytial aggregates, nuclear crowding and overlapping are also often seen.
The repetitive smear pattern with uniform cell population is in contrast to the variable pattern of different cell types seen in colloid and hyperplastic nodules. Microacinar clusters with a central lumen (that may contain a drop of colloid) represent microfollicles (Figs 6.18, 6.19 and 6.21B). These are characteristic of FN but may be found focally in NG. Rosette-like groupings without a lumen (Fig. 6.20) suggest a more solid growth pattern. A trabecular pattern is represented by rows and elongated aggregates of epithelial cells that resemble papillary structures when they adhere to strands of vascular stroma (see Fig. 6.33B,C). Small blood vessels with adherent epithelial cells can be found in any type of follicular neoplasm (see Fig. 6.25A).
The distinction between FN and NG is the most common differential diagnostic problem in solitary nodules as cytological appearances overlap (Fig. 6.22). A microfollicular focus in a colloid nodule cytologically resembles a microfollicular neoplasm, while smears from a macrofollicular (colloid) adenoma resemble a dominant nodule in multinodular goiter. Jaffar122 indicated that the presence of hemosiderin within macrophages and follicular cells excludes FN. The false-negative rate of cytology in FN may be 30% or more because of the inability to recognize normofollicular neoplasms.123 However, these distinctions are of little clinical importance as long as the nodule is recognized as benign and spared from unnecessary surgery.
Most FCs are microfollicular, trabecular or solid, contain little colloid, and will be reported as ‘FN’ by cytology. Although the failure to recognize FC as neoplastic has been surprisingly high in some series,7 other studies show high diagnostic sensitivity, with false-negative rates as low as 0–2%.11,13,28
Cytological features in FA and FC are similar, with cellular smears composed of syncytial clusters of crowded cells. There is a tendency for uniform nuclear enlargement in FC, whereas FA may show small or large nuclei.124 These differences are often subtle, with much overlapping (Fig. 6.20).3,68,125 Cells from a well-differentiated but clinically aggressive FC may not appear obviously atypical or enlarged in smears (Figs 6.23, 6.24B). Anisokaryosis per se is more a feature of non-neoplastic lesions such as NG and thyroiditis.42
Most authors are content to use cytology to select cellular FNs for follow-up or surgical excision, and to leave a diagnosis of malignancy to histological assessment of capsular and vascular invasion. Reporting cytological atypia and any suspicion of malignancy, although not diagnostic, may be of some use in making the choice between follow-up and immediate surgical excision. The ultimate prognosis of microfollicular, solid or trabecular adenomas is uncertain and these should probably be excised anyway.
FC has been considered the second most common thyroid cancer, accounting for 10–20% of all thyroid malignancies.126 The proportion of carcinoma in lesions designated as FN has been reported as ranging from 14% to 44% in previous series.3,119 In a large series of operated cases from 1994 to 2002 from Bethesda,127 an 18.2% rate of malignancy was found in cases in which a cytological diagnosis of ‘possible FN’ was given and 20.9% in cases with a definitive cytological categorization of ‘FN’.
Clinicians (and cytopathologists) are conventionally preoccupied with the inability of cytologically distinguishing FA from FC, leading to numerous ancillary investigations to help make this distinction. Computer assisted cell morphometry, ploidy analysis and determination of AgNORs in cytological smears have been tried with variable success.61,128,129 Results of proton magnetic resonance spectroscopy have been encouraging.130 However, the most promising technique for the future is probably immunocytochemical demonstration of molecular markers.131 Positive immunostaining with CD44v6 or galectin 3 (with a score of G2) in combination with FNA54,55 have been noted to be useful in cases with indeterminate cytology.56 Telomerase activity58 and microarray analysis of cytologic samples59 are other ancillary tests that may aid in distinguishing benign from malignant follicular lesions.
Interestingly, there are studies indicating that FC is gradually becoming a rare entity.18,22,24,132,133 Prevalence of malignancy in operated cases of FN118 was 31%, and 9% of these were follicular or Hurthle cell carcinomas. The incidence of FC was only 2% of thyroid cancers in LiVolsi’s series24 and 1% at the University of Chicago Medical Center.22 Discussing the gradual demise of FC, De May22 opined that independent of the quality of any diagnostic test employed, statistically speaking, its predictive value would be affected by the prevalence of the disease in question. It stood to reason therefore that, if the prevalence of FC is low, the predictive value of cytology for FC would also tend to be low, although cytology is otherwise an excellent diagnostic modality.
Atypical adenomas show foci of extremely pleomorphic cells that cytologically simulate malignancy (Fig. 6.24A). These are designated as carcinoma only if there is capsular or vascular invasion. Nuclear pleomorphism is not a common feature of well-differentiated FC and is not considered a cytological criterion of malignancy. On the other hand, it is frequent in dyshormonogenetic goiter, treated GD, and following chemotherapy and radiotherapy.42,85
In recent years, FV-PC has attracted much attention. Due to the presence of follicular groupings and colloid in these tumors (see Fig. 6.43), it constitutes a generous proportion of malignancies reported as FN.21,22,118 However, a proportion of nuclei display typical cytological features of PC (described below in section on PC). In some series, high cytologic accuracy rates for FV-PC134 with 93–94% sensitivity, specificity, positive and negative predictive values have been demonstrated using ultrafast PAP stain.135
No cytological criteria clearly distinguish parathyroid from follicular thyroid neoplasms.136 Agarwal et al.,137performing US-guided FNA of 53 parathyroid adenomas, reported low sensitivity as a major limitation. Smears showed moderate cellularity with monomorphous, round to slightly oval cells predominantly arranged in loose two-dimensional clusters with occasional papillary fragments. The majority of them exhibited stippled nuclear chromatin and bare nuclei were seen in the background. There was no significant pleomorphism, mitotic activity, or prominent nucleoli. Parathyroid adenomas are usually not palpable but radiological examination is capable of locating most non-palpable parathyroid lesions. However, the occasional parathyroid adenoma may be intrathyroidal.138 Cytohistological overlap in parathyroid and thyroid follicular lesions can be a problem at the time of frozen section evaluation, and intraoperative parathyroid hormone monitoring may be required. In parathyroid carcinomas, clinical, biochemical and radiological findings are usually characteristic. Cytology, combined with clinical, radiological and immunocytochemical findings can enhance diagnostic accuracy.139 Tseleni-Balafouta140 felt that due to overlapping morphological features, in order to avoid surgical mismanagement, the possibility of a parathyroid lesion should be stated clearly in cytology reports in all colloid-free cellular follicular lesions. Parathyroid incidentalomas comprise 0.4% of lesions in patients referred for suspected thyroid nodules, and parathyroid hormone analysis in FNA washouts has been found to be a diagnostic aid.141
FNs are often highly vascular and aspiration of blood may obscure neoplastic cells. It should be understood that excessively blood-stained smears are not necessarily related to poor technique but may signal the possibility of a neoplasm. Repeat needling using the fine needle capillary sampling technique with a 26 or 27-gauge needle after a gap of a week or two often yields diagnostic material.
Colloid in small follicles is often very dense and may be laminated, but the regular edge is unlike that of a psammoma body.
Variants of follicular neoplasms


Fig. 6.25 Oxyphil (Hurthle cell) adenoma
(A) Sheets of oxyphil cells adherent to capillary blood vessels; histology oxyphil adenoma; (B) Oxyphil cells in a trabecular arrangement; histology oxyphil adenoma (MGG, HP).


Fig. 6.26 Hurthle cell carcinoma
(A) Similar pattern as Figure 6.25B of trabecular groups of oxyphil cells (MGG, HP); (B) Large polygonal cells with well-defined cell margins, basophilic cytoplasm, vesicular nuclei and macronucleoli (MGG, HP).
HCTs, constituting 1.5–10% of thyroid tumors, represent a controversial pathological entity,142 regarding both their behavior and classification (whether they represent metaplasia in follicular or papillary neoplasms or constitute a distinct entity). Most tumors are encapsulated, and capsular and/or vascular permeation are standard criteria of malignancy. Recent reports suggest that Hurthle cell carcinoma may be a more aggressive tumor, distinct from FC.143 Rare familial cases of aggressive, metastasising Hurthle cell carcinoma have been reported.144
Smears from HCT yield abundant material consisting of large, polygonal Hurthle cells with oval nuclei and abundant, well-defined, granular cytoplasm. Tumor cells appear singly, in acinar arrangement, and in monolayered sheets of variable sizes.145,146 Nuclei are eccentrically placed. Occasional cells may be ovoid or rounded. Nuclear pleomorphism may be present but is not as common in adenomas as in non-neoplastic lesions like HT. Occasional small syncytial tumor cell clusters and naked nuclei may be seen. Carcinomas show relatively smaller Hurthle cells with monomorphic or pleomorphic nuclei, macronucleoli and ill-defined cytoplasm. Crowded sheets, syncytial tumor cell clusters of variable sizes and naked nuclei may be present.90 Computerized interactive morphometric analysis of nucleolar features may be helpful in distinguishing benign from malignant lesions.147 However, due to frequent morphological overlap, a cytological diagnosis of HCT is preferred, with further categorization deferred for histological study. Galectin 3 immunostain has been shown to stain Hurthle cell adenomas.55 Combination of galectin 3 and HBME has been demonstrated to show 99% sensitivity and 88% specificity in tumors composed of Hurthle cells (Hurthle cell adenomas, carcinomas and oncocytic variant of PC).148
Hurthle cells are seen in a variety of non-neoplastic lesions such as NG, GD, HT and GT. In most of these conditions, they are admixed with other cells that indicate the nature of the lesion, such as lymphoplasmacytic cells in HT, epithelioid cells in GT, etc. A mixture of Hurthle cells and ‘normal’ follicular epithelial cells is more consistent with a hyperplastic nodule.99,146 In early stages of HT, needling of proliferating Hurthle cell nodules may lead to a smear pattern dominated by Hurthle cells. The presence of a high percentage of dyshesive Hurthle cells with large nucleoli, with some cells showing significant nuclear enlargement and pleomorphism, are indicative of a neoplastic Hurthle cell lesion.99,146 Flat sheets of Hurthle cells are more characteristic of thyroiditis, poorly organized and poorly cohesive cell clusters of neoplasia.100 Neoplastic and non-neoplastic Hurthle cell nodules may develop following irradiation to the head and neck.149 Smears in such cases often suggest a neoplastic lesion. These nodules should be excised for careful histological evaluation.
Atypical adenoma with bizarre cells has been discussed above. A rule applicable to all endocrine organs is that nuclear pleomorphism per se cannot be used as a basis for cytological diagnosis of malignancy.
Clear cell change in follicular epithelium may be due to accumulation of glycogen, thyroglobulin, mucin, lipid or varying combinations of these.90 It may also represent artifacts of formalin fixation or paraffin embedding.42 While clear cell morphology is well appreciated in tissue sections, cytologic smears show cells with abundant, finely vacuolated, pale but not totally clear cytoplasm (Fig. 6.27). Clear cell change may be a focal or less frequently diffuse phenomenon in FA, FC, HCT42 and non-neoplastic lesions. Metastatic clear cell carcinoma of renal origin is an important differential diagnosis.42 Signet ring adenoma containing thyroglobulin as well as mucin, PAS-D and acidic Alcian blue-positive material is a rare finding and could be due to the presence of protein polysaccharide complexes derived from partial degradation of thyroglobulin.150
Poorly differentiated thyroid carcinoma
Until recently, thyroid carcinoma with a poorly differentiated insular pattern was considered to be a distinct entity, a thyroglobulin-producing neoplasm, intermediate in aggressiveness between well-differentiated and anaplastic thyroid carcinoma. Reports have appeared documenting cytological features in insular carcinomas such as high cellularity, dispersed and loosely aggregated cells, solid, cohesive trabecular or papillaroid structures, intact insulae, fragile, ill-defined, granular cytoplasm, oval, hyperchromatic nuclei, occasional INCIs and/or grooves.151-155 However, as insular pattern is often admixed with trabecular and solid growth patterns, the more suitable term ‘primordial carcinoma’ was suggested for this entity.156
The current concept of pure poorly differentiated thyroid carcinoma, as per the Turin proposal156 is one that shows a histologically mixed solid/trabecular/insular architecture, absence of conventional nuclear features of PC and the presence of one of the following three features: cells with convoluted (raisin-like) nuclei, a mitotic index of ≥3 mitoses/10 high-power fields and tumor necrosis. Most tumors are immunohistochemically positive for thyroglobulin and thyroid transcription factor 1, and a subset is also positive for p53.157 Ras mutations are common.
Smears in poorly differentiated thyroid carcinomas are hypercellular with single cells as well as cells in solid, trabecular and insular patterns. There is marked crowding of cells and tumor cells show high nuclear cytoplasmic ratios (Fig. 6.28).158



Fig. 6.28 Poorly differentiated carcinoma
(A,B) Smears showing syncytial clusters of crowded small cells with hyperchromatic nuclei (A, MGG, HP; B, Pap, HP); (C) Tissue section, same case. (H&E, IP).
Distinction from metastatic carcinomas (Fig. 6.29), especially on cytologic smears, requires detailed clinical evaluation, review of sections of previous surgery, prior cytologic smears, if any, and use of ancillary stains (thyroglobulin and TTF-1) where necessary.

Fig. 6.29 Metastatic carcinoma in thyroid
Metastasis to thyroid of breast carcinoma; smear pattern similar to poorly differentiated carcinoma as in Figure 6.28 (Pap, HP).
Differentiated thyroid carcinomas, especially FC, may show poorly differentiated foci that may be sampled by the needle, missing out the well-differentiated component. MC of small cell type can be distinguished by calcitonin immunostaining.
Papillary carcinoma (Figs 6.30-6.47)159-162
Diagnostic criteria
Papillary carcinoma (PC) is the most common type of thyroid cancer, occurring predominantly in females, in all age groups but most often in the third to fifth decades.42 It accounts for 90% of childhood thyroid malignancies. Five to ten percent of cases have had prior head and neck irradiation, usually in the first two decades of life. Most cases show clinically evident metastatic cervical lymphadenopathy at presentation, yet the prognosis is usually good, especially in children and young adults. RET/PTC rearrangements and BRAF mutation are often seen.159 PC is rarely encapsulated, infiltrates the thyroid in an irregular manner and is often multifocal with variable degrees of cystic change. Histological hallmarks of the tumor are the branching papillary structures with fibrovascular cores, lined by cuboidal or columnar cells with ‘ground-glass’ nuclei (‘Orphan Annie’ eyes). These cells show nuclear grooves and/or INCIs, and psammoma bodies are seen in many cases.
Smears in PC are cellular with numerous three-dimensional and papillary fragments (Fig. 6.30) with or without vascular cores. Often, papillae not removed intact by the needle appear as flat sheets. Sheets of cells show a distinct anatomical border, formed by a row of cuboidal or columnar cells (Fig 6.31A) with focal nuclear crowding and overlapping, features that distinguish sheets of PC from those representing benign macrofollicles (Fig. 6.31B). The tip of a papilla may be seen as a finger-like aggregate of cells with a similar edge (Figs 6.32 and 6.33A). Naked true papillary connective tissue cores are sometimes found and can be diagnostically helpful. Trabecular fragments (Fig. 6.33B) (also present in FN) are represented in smears by cohesive finger-like structures and must not be mistaken for papillae. Seventeen percent of cases show concentrically organized aggregates of tumor cells or ‘swirls’ (Fig. 6.34), the most peripherally located cells appearing ovoid with nuclei oriented perpendicular to the radius of the swirl.163 A few cases show only dispersed single cells and syncytial aggregates; diagnosis then relies on identification of nuclear features of PC.

True papillary fragment with a vascular core; columnar cells with oval pale nuclei; intranuclear vacuoles, upper left (MGG, IP).


Fig. 6.31 Comparison of sheets of papillary carcinoma and of macrofollicle in nodular goiter
(A) Papillary carcinoma. Flat sheet of epithelial cells; partly monolayered, partly with nuclear overlapping; uniformly enlarged, oval nuclei with pale powdery chromatin and small nucleoli; note ‘anatomical’ edge of a row of cells along upper edge (Pap, HP); (B) Nodular goiter. Flat monolayered sheet of cells from a disrupted macrofollicle; note frayed edges and uniformly small round nuclei (Pap, HP).



Fig. 6.33 ‘Papillary’ structures
(A) Finger-like papilla of papillary carcinoma; distinct lining on three sides by a row of cuboidal/columnar cells (H&E, IP); (B) Finger-like, pseudopapillary fragment from a trabecular thyroid carcinoma (Pap, HP); (C) Tissue section from same case as B (H&E, IP).

Fig. 6.34 Papillary carcinoma, swirls
Concentrically arranged tumor cells forming swirls with peripherally located cells appearing perpendicular to radius of the swirl (MGG, HP).
Tumor cells show uniform enlargement with dense cytoplasm and well-defined cell borders. INCIs (Fig. 6.35), characteristic of PC, are seen in up to 90% of cases. They are seen in 5% of the cells (10% if examined under oil immersion under 2–3 planes of focus).164,165 INCIs, however, are not specific to PC as they can be seen in atypical adenomas,166 hyalinizing trabecular tumors,167 MC (see Fig. 6.55),168 AC (see Fig. 6.59) and rarely in FC,90 HT18 and juxta-thyroidal neoplasms (parathyroid adenoma, paraganglioma, etc.).67,90

Fig. 6.35 Papillary carcinoma, intranuclear ‘vacuoles’
Large, oval, pale nuclei; several intranuclear cytoplasmic inclusions; pale powdery chromatin most obvious in Pap; note cells with convoluted nuclei in B (A, MGG; B, Pap, HP oil).
INCIs have sharp, well-defined, membrane-like margins and are not optically clear but resemble the cytoplasmic color and texture. They probably start as trapped cytoplasm in deep nuclear folds (grooves)169 that eventually invaginate into the nucleus at foci of nuclear membrane weakness. Grooves and inclusions do not usually coexist, possibly due to the pressure of the inclusion unfolding the groove and preventing further groove formation.170 Artifacts such as superimposed air bubbles or fat droplets can mimic INCIs both in PAP- and MGG-stained material.27,171 Optically clear vacuoles and poorly defined central areas of pallor (MGG) should not be accepted as inclusions. The clear or ground-glass (‘Orphan Annie’) nuclei seen in tissue sections are represented in smears by very fine, powdery nuclear chromatin,164 an important diagnostic criterion and a feature best appreciated in ethanol-fixed, PAP-stained smears (Figs 6.35 and 6.36).
Irregular nuclear shapes, convolutions (Fig. 6.35B) and longitudinal nuclear grooves or creases (Fig. 6.36) are visible in cytologic smears (in 85–100% cases) and in sections.165,170 Grooves are obvious in alcohol-fixed material but are difficult to discern in MGG preparations. Strict criteria for recognition have been suggested: continuous grooves or creases, clearly defined and running the length of the nucleus.172 The presence in ≥20% of cells, as counted in selective fields where grooves are frequent, is highly predictive of PC.173 Grooves, however, may be found in small numbers in 70–80% of non-papillary neoplasms, in 50–60% of non-neoplastic thyroid lesions172 and in a variety of extrathyroid tumors; hence, metastatic carcinoma and melanoma are included in differential diagnoses.42

Sheet of cells with large, very pale (but not optically clear) crowded nuclei; powdery chromatin; many longitudinal grooves (Pap, HP oil).
Tumor cells often show delicate soap-bubble like cytoplasmic vacuolation (septate cytoplasmic vacuoles)174or squamoid cytoplasm (metaplastic cells). Dense cytoplasm and well-defined cell margins may simulate Hurthle cells (Fig. 6.37) or squamous cells (Fig. 6.38A). True squamous metaplasia and Hurthle cell change may be present. Cells with abundant vacuolated cytoplasm are seen (Fig. 6.38B) resembling histiocytes (foam cells) but with nuclear features of PC.162 Such ‘foam cell metaplasia’ is seen in about 50% of PCs and is best appreciated at the edges of the smear.42 Foam cell metaplasia may also be seen in cystic NG with papillary hyperplasia42 and in papillary breast lesions. Macrophages and cell debris may be prominent, especially when cystic change is present. Multinucleate giant cells are frequently seen and, if numerous, have been shown to be associated with larger tumor size and greater likelihood of extrathyroidal extension.175 Lymphoid cells are present in 30% of cases.176

Poorly cohesive cells and a micropapillary cluster; psammoma bodies; abundant dense cytoplasm with distinct cell borders; uniform large nuclei, some nuclear crowding and overlapping (MGG, HP).

Fig. 6.38 Papillary carcinoma, ‘metaplastic’ cells
(A) Poorly cohesive cells with large, pale, oval nuclei, a few with grooves; some cells with dense ‘metaplastic’ squamoid cytoplasm (Pap, HP); (B) ‘Metaplastic’ cells resembling macrophages, but with nuclear features of papillary carcinoma (Pap, HP oil).
‘Chewing gum’ colloid presents as strands or chunks of dense, dark-blue (MGG) colloid, rather unlike the colloid found in other thyroid diseases (Fig. 6.39). Concentric, lamellated, calcified (psammoma) bodies are seen in cytological smears in 0–25% of cases.177 They look glassy and refractile, measure about 100 µm, stain dark blue with MGG and red with PAP stain, and show concentric lamellations (Fig. 6.40) that distinguish them from non-specific degenerative calcium granules seen in many thyroid lesions. Although not specific to PC, when present in non-neoplastic thyroid tissue or lymph nodes they are an important clue to the presence of occult PC. In smears containing psammoma bodies, laminated hyaline globules, branching hyaline cylinders and irregular hyaline deposits can be seen.178 Rarely, they show varying numbers of concentric layers of calcium in between the hyaline layers, suggesting an early or precursor form of psammoma bodies (intracellular, targetoid, possible precursor substances were reported in one case).179

Thick, ropy ‘chewing gum’ colloid; sheets of cells with enlarged ovoid pale nuclei; some ‘metaplastic’ ’cells (MGG, IP).

(A) Psammoma bodies showing concentric lamellation and variable staining, partly dark blue (MGG, HP oil); (B) Follicular epithelial cells surrounding a central cluster of calcific bodies from a benign colloid nodule with cystic change (Pap, HP).
Multiple criteria must be observed before making a confident cytological diagnosis of PC.160,162 Logistic regression analysis of the various criteria suggested that a combination of INCIs, papillary structures without adherent blood vessels and dense ‘metaplastic’ cytoplasm were the three most important variables.161 The presence of ≥3 of the following features – papillae, psammoma bodies, nuclear grooves, INCIs and fine granular chromatin – has been reported to facilitate cytological diagnosis of PC, with frequent grooves and INCIs being the most dependable.164 Sensitivity and predictive value of cytological diagnosis in several large series ranged from 60% to over 90%.30,160,161 Nuclear enlargement, atypia and nucleoli are reported to relate to recurrence.180 BRAF oncogene mutation, associated with extrathyroidal extension, recurrence and lymph node metastasis, can be identified in cytologic material and can help in optimizing treatment.181
As in FC, PC cells show dual immunostaining for cytokeratin and vimentin, a feature of help in identification of distant metastases as of thyroid origin. Immunostaining for cytokeratin 19, CD44, galectin 3 and p63 have been reported to be of value in the diagnosis of PC.182-184 Nga et al.185 reported the combination of positive HBME-1 (luminal/membranous) and CK19 (cytoplasmic) staining on smears from PC.
Fluid aspirated from cystic PC is uncharacteristic, brown or resembles altered blood. The diagnosis can easily be missed if well-preserved epithelial cells are scarce (Fig. 6.41).30,31,71 Presence of numerous macrophages, with many in cohesive clusters, should raise a suspicion of PC. Some of these cells are probably degenerating tumor cells exfoliated from the cyst lining (Fig. 6.42). They may represent foam cell metaplasia in tumor cells, and careful scrutiny will usually reveal nuclear features of PC. Large cell size, pseudoinclusions, nuclear grooves, and multiple well-defined vacuoles in atypical histiocytoid cells favor a diagnosis of PC.186

Fig. 6.41 Cystic papillary carcinoma
Cystic change in metastatic papillary carcinoma in cervical lymph node; mainly foamy cells with some pigment resembling macrophages; one cluster of degenerate atypical epithelial cells (MGG, HP).


Fig. 6.42 Cystic papillary carcinoma
(A) Fluid from cystic papillary carcinoma; numerous macrophages, many with pigment, some clustered; a few nuclei with longitudinal grooves; no well-preserved epithelial cells (Pap, HP); (B) Tissue section from a cystic metastatic deposit in lymph node from same case; transition from intact neoplastic epithelium lining the cyst to exfoliated degenerating epithelial cells to ‘macrophages’ with intracytoplasmic pigment (HE, IP).
Tumor cells and tumor fragments in cyst fluid often show attenuation due to pressure of the cyst fluid and may not be recognizable as such in cytological and histological preparations. The sensitivity of FNA diagnosis in cystic neoplasms may be as low as 40%,31 and all cystic lesions should be managed cautiously. Combining clinical and cytological criteria and using US-guidance while needling minimize false-negative diagnoses.15 Cervical node metastases of PC are also often cystic and may not yield well-preserved diagnostic epithelial cells; the possibility of metastatic PC should be considered if samples of an abnormal cervical node contain only blood, fluid and histiocytes.
Smears from PC that show lymphocytes and multinucleated giant cells may simulate HT,42 especially the diffuse sclerosing variant of PC that shows heavy lymphocytic infiltration. Close scrutiny of nuclear features is essential to avoid false-negative diagnosis. Infiltration of follicular and Hurthle cells by lymphoid cells is suggestive of HT, papillary and three-dimensional clusters of cells indicate PC. HT and PC may coexist.109,187
Hurthle cell metaplasia of tumor cells may simulate HCT. If all of the tumor cells are of Hurthle cell type, an oxyphilic (Hurthle cell) variant of PC should be considered (described below).
Papillary foci (with rare psammoma bodies) are present in hyperplastic NG and in GD.188 Such hyperplastic lesions lack nuclear features of PC.
Distinction from hyalinizing trabecular tumor is discussed below.
Many features of PC, such as INCIs, grooves, papillary structures and psammoma bodies, can be seen singly or in various combinations in other neoplasms and non-neoplastic lesions. Calcific debris and inspissated colloid may mimic psammoma bodies, as can also oxalate crystals in benign thyroid lesions, but the latter are birefringent. Intraluminal colloid-associated concretions in clear cell FNs may mimic psammoma bodies. Histiocytic cells in cystic NG can mimic nuclear features of PC; immunostaining for CD68 can be useful in their distinction. Cytological diagnosis of PC should never be made from isolated cytologic characteristics but from the composite cytological picture correlated with the clinical profile. Artifacts occurring during specimen preparation and handling issues such as decalcification, frozen section, and artifacts following FNA are discussed in detail by Baloch and LiVolsi.189
Distinction of FV-PC from FN is described in detail in the section on FV-PC. The value of combining CK19 and HBME 1 immunostains has already been described above.185
Variants of papillary carcinoma
Follicular variant of PC134,190-192
This has attracted great interest in recent years, probably due to difficulties in its cytological distinction from FN. The tumor shows a follicular architecture with a proportion of cells showing nuclear features of PC such as powdery pale chromatin and nuclear grooves. INCIs are less frequent. Pink colloid balls may be present. However, overall cytological features are more akin to FN such as colloid, dispersed cells, acinar and syncytial clusters (Fig. 6.43). Ninety-three to ninety-four percent cytological sensitivity and specificity have been reported in some series,135 while other studies show that a variable proportion of nodules designated as FN proved to be FV-PC.18,22,118 The advantage of imprint smears over frozen section was stated earlier. Recent studies indicate that FV-PC may be a heterogeneous disease composed of an infiltrative/diffuse (non-encapsulated) subvariant resembling classic PC in invasiveness and metastatic nodal pattern and an encapsulated form that behaves more like FN.193
Macrofollicular encapsulated variant
Characterized histologically by predominance of macrofollicles with nuclear features of PC, this may be diagnosed on cytology as a macrofollicular adenoma or NG.194,195 Smears show large, cuboidal cells with fine nuclear chromatin, grooves, pseudoinclusions and dense eosinophilic colloid.195
Oncocytic variant (Fig. 6.44A,B)
This variant shows papillary and follicular structures populated by oncocytes with abundant, coarsely granular cytoplasm and nuclear features of PC. Smears show papillae and three-dimensional clusters of oncocytes, some with vascular cores.42,196 INCIs and grooves are present. Maconucleoli are absent, an important distinguishing feature196 from papillary HCT.146 Differential diagnosis includes HT that is rarely associated with this variant. As this tumor is often associated with local invasion and can involve cervical lymph nodes, it may require more extensive surgery than classic PC.
Warthin tumor-like variant
This tumor is characterized by oncocytic tumor cells with nuclear features of PC lining papillary structures, and brisk lymphoplasmacytic infiltrates in the papillary stalks.197 RET/PTC expression suggests a possible relationship to the oncocytic variant of PC.198 Cytologically, these lesions appear to be a combination of PC and HT.42,197 The oncocytes are present as single cells, cohesive and three-dimensional clusters and papillae, show granular eosinophilic cytoplasm, eccentric nuclei, prominent nucleoli and nuclear atypia. Lymphocytes and plasma cells intercalate with the cell clusters, imparting the ‘ants at a picnic’ appearance of HT.
Cribriform-morular variant199,200
This rare subtype is characterized by an admixture of cribriform structures, closely packed follicles, papillae and solid areas with islands of squamoid morules. Some cases show association with familial adenomatous polyposis. Smears show squamoid morules, cribriform structures without colloid, spindle cell whorls and papillae lined by pseudostratified columnar cells. Nuclear chromatin is fine and powdery with occasional grooves and inclusions.
Adenoid cystic variant201,202
Smears show papilliform clusters, monolayered sheets, psammoma bodies, many nuclear grooves and INCIs. Follicular formations with colloid are seen, some showing light pink to deep purple hyaline globules giving a laminated appearance and surrounded by neoplastic cells, reminiscent of adenoid cystic carcinoma.201 Thyroglobulin stained the colloid and follicular cells but not the hyaline globules. Von Kossa stained the psammoma bodies and some of the hyaline globules, suggesting that these globules may be evolving psammoma bodies.
PC with nodular fasciitis-like stroma
Smears show a prominent stromal component with bland spindle cells.203 Stromal fragments are of irregular shape and size, with extracellular matrix and desmoplasia. Sparse epithelial cell groups show features of PC.
High-grade variants of PC
These variants of PC are clinically more aggressive than the usual type.
Tall cell variant (Fig. 6.45)134
This tumor shows solid areas, follicles and papillae lined by oxyphilic cells twice as tall as they are wide with nuclear clearing, grooves and inclusions. Smears show oxyphilic cells with reddish or cyanophilic, granular, septated, or vacuolated cytoplasm, frequent nuclear grooves and inclusions. Lymphocytes are often present. Tadpole-like cells with basal, eccentric nuclei and high MIB-1 labeling have been reported.204
Columnar cell variant205,206
The least common variant of PC, this tumor has an aggressive course if unencapsulated. It shows a mixed papillary, follicular and solid growth pattern with tall columnar, pseudostratified cells lining papilloglandular structures. Smears show papillary and follicular structures lined by tall columnar, pseudostratified cells that resemble respiratory epithelium (Fig. 6.46).206 Nuclear grooves and inclusions are usually not seen. Dispersed plasmacytoid cells with eccentric nuclei and focal squamous metaplasia may be present.
Diffuse sclerosing variant95,207
Histologically, this tumor shows prominent fibrosis, a papillary pattern, squamous metaplasia and many psammoma bodies with moderate lymphoplasmacytic infiltrates. Scattered microcalcifications impart a ‘snow-storm’ appearance to the US. Clues to cytologic diagnosis are prominence of squamous metaplastic cells, psammoma bodies (Fig. 6.47) and lymphocytes intermingled with tumor cells. INCIs and grooves are present.
Solid/trabecular variant
Comprising 3% of PC, this tumor has an aggressive course in adults but not in children, where it is associated with radiation exposure.156 Fifty to seventy peercent of the tumor shows a trabecular and/or solid pattern. Nuclear features of PC are seen. Smears show solid masses and anastamotic, 2–10-cell thick trabecular cords, separated by endothelium-lined vascular spaces.208 Tumor cells show irregular nuclear contours, with some showing grooves and inclusions.
Hyalinizing trabecular tumor (Fig. 6.48)167,209,210
This is a rare thyroid tumor of follicular cell origin with a trabecular pattern of growth and marked intratrabecular hyalinization. It has been mistaken on cytology for MC and paraganglioma with which it shares morphological and architectural similarities. Smears show medium-sized, round, oval or polyhedral cells arranged individually, in small groups or parallel arrays. Cells show low nuclear cytoplasmic ratios with moderate to abundant cytoplasm. Nuclei may be eccentrically placed with focal binucleate forms that resemble Hurthle cells or MC. Cohesive aggregates are radially oriented around hyaline material. Nuclear grooves and inclusions, seen in some cases,167 may simulate PC, while dispersed cell pattern and amorphous amyloid-like or hyaline material in the smears may resemble MC. Intracytoplasmic ‘yellow bodies’ (giant lysosomes) have been described.210

Fig. 6.48 Hyalinizing trabecular tumor
(A) Smear showing tumor cells arranged individually, in small groups and parallel arrays with a few binucleate forms; (B) Tissue section showing tumor with trabecular pattern, intervening areas of hyalinization, and focal binucleate cells.
The presence of RET/PTC1 translocations211 suggests that it may be a variant of PC, but BRAF and ras mutations are absent. Strong peripheral cytoplasmic and membranous MIB-1 staining is present.212 Cases of malignant hyalinizing trabecular tumor have been recorded. However, since most reported cases behaved in a benign fashion, it is considered a benign neoplasm or one of extremely low malignant potential.211
Medullary carcinoma (Figs 6.49-6.57)90,213-222


(A) Poorly cohesive cells with a ‘plasmacytoid’ appearance and moderate anisokaryosis, fragments of magenta-colored amyloid; (B) Cellular smear from another case; dispersed epithelial cells, some lined up in curved rows; anisokaryosis, many cells with two or more nuclei; stippled chromatin; a few tiny specks of amyloid (MGG, HP).

Dispersed cells with a ‘plasmacytoid’ appearance and several binucleate forms; dark nuclei (Pap, HP).

(A) ‘Plasmacytoid’ cells with abundant well-defined cytoplasm and eccentric nuclei; note clump of magenta-colored amyloid (MGG, HP); (B) Binucleate tumor cell with coarse, red intracytoplasmic granules (MGG, HP oil).

Fig. 6.52 Medullary carcinoma, small-cell pattern
Densely clustered cells with ovoid crowded hyperchromatic nuclei; nuclear molding (MGG, HP).


Fig. 6.53 Medullary carcinoma, amyloid
(A) Clumps of hyaline material staining a magenta color with MGG; (B) Same in Pap staining pale grayish-green to orange (HP oil).


Fig. 6.54 Medullary carcinoma, spindle cell variant
(A) Dispersed and clustered spindle cells with elongated nuclei mimicking a mesenchymal neoplasm (MGG, IP); (B) Spindle cells with speckled nuclear chromatin (Pap, HP).

Fig. 6.56 Medullary carcinoma, giant cell variant
Large pleomorphic cells resembling anaplastic carcinoma. The cells were strongly positive for calcitonin (MGG, HP).


Fig. 6.57 Mixed medullary and follicular carcinoma
(A) A cellular smear of dispersed cells consistent with medullary carcinoma but with some distinctly microfollicular structures (lower right) (MGG, HP); (B) Microfollicle highlighted by positive thyroglobulin staining; (C) Most cells are calcitonin positive; some groups negative (immunoperoxidase, same case).
Medullary carcinomas (MCs) constitute 5–10% of thyroid cancers216 and are familial or sporadic with RET proto-oncogene mutations implicated in the former.217 They are solid, firm, non-encapsulated tumors that show calcitonin-positive, round, polygonal and/or spindle cells in solid, nest-like and organoid patterns in a vascular stroma containing amyloid.42
Smears in MC are cellular in a background of blood. The cell pattern is predominantly dissociated with round, oval, polygonal and spindle cells in varying combinations. Plasmacytoid cells or triangular cells with eccentric nuclei are common and they show moderate amounts of cytoplasm with well-defined cell margins (Figs 6.49 A, 6.50 and 6.51 A). The small cell type shows scanty cytoplasm, high nuclear cytoplasmic ratio and ovoid nuclei, forming dense clusters, often with nuclear molding (Fig. 6.52). The spindle cell pattern shows cells with elongated, relatively pale nuclei and indistinct attenuated cytoplasm, resembling benign or low-grade spindle cell soft tissue tumors (Fig. 6.54). Nuclear chromatin may be fine and stippled (neuroendocrine-like) or coarsely granular. INCIs have been noted in occasional single cells in up to 55% of cases (Fig. 6.55).42,90,218
Anisocytosis is frequent with binucleate, trinucleate and multinucleate forms. Appearances may range from monomorphic (carcinoid-like) to markedly pleomorphic, mimicking AC.213 Follicular or pseudopapillary patterns may be present.
Some of the cells show coarse reddish cytoplasmic granules (Fig. 6.51B) in Diff-Quik and MGG-stained smears, corresponding to neurosecretory granules seen on electron microscopy. Calcitonin is prominently present in the granular cells. Amyloid, present in 50–80% of cytological material from MC, 42 appears as dense amorphous clumps, staining variable shades of magenta with MGG and grayish-orange with PAP (Fig. 6.53). Cracking artifacts may be present. Congo-red staining and dichroism confirm the material as amyloid (which may otherwise be confused with hyaline connective tissue, condensed colloid or stroma of hyalinizing trabecular tumor).
Cytologic features suggestive of secretory activity such as cytoplasmic vacuoles, azurophilic granules, marginal vacuoles, and intracytoplasmic lumina with secretions have been reported.218 Amyloid-like, intracellular and extracellular material was present that stained with calcitonin, as also the intracytoplasmic lumina. In cytologic smears, calcitonin-positive secretory material appeared to be diffusing out of cells.
Immunocalcitonin staining supports and greatly improves the accuracy of cytological diagnosis in MC.214,215 The stain works well in air-dried, de-stained and wet-fixed smears and cell block preparations. If calcitonin staining is weak or equivocal, staining for chromogranin and/or carcinoembryonic antigen can be done. Electron microscopic study for demonstration of neurosecretory granules has been largely replaced by immunocytochemistry.
Papillary, oncocytic, giant cell, small cell, mucinous, squamoid, pigmented and clear cell variants of MC have been described. The small cell variant (Fig. 6.52) is difficult to distinguish from poorly differentiated carcinoma, metastatic small cell carcinoma and malignant lymphoma, the spindle cell variant (Fig. 6.54) from spindle cell mesenchymal lesions and melanoma and the giant cell type (Fig. 6.56) from AC.
Giant cells in MC usually show variation in cell size but not of cell type, as in anaplastic giant cell carcinoma, and bizarre mitoses are uncommon.213 The oncocytic variant resembles HCT, but cytoplasmic granules in MC are reddish and macronucleoli not as common as in HCT.42 The papillary variant may show true papillae, INCIs and psammoma bodies. PC cells, however, show dense, non-granular cytoplasm. Definitive diagnosis requires ancillary stains/techniques. The small cell variant may be calcitonin-negative and positive for keratin and pan-endocrine markers; thus detailed clinical work-up is required to rule out metastatic small cell carcinoma.
Mixed MC and FC (Fig. 6.57)219A can be confused with microfollicular pattern in MC, especially if amyloid has been mistaken for colloid. The dual cell population can be highlighted by staining for calcitonin and thyroglobulin (Fig. 6.57B,C) but the possibility of residual follicles being trapped by tumor may be difficult to rule out.
Cytomorphologic overlap and distinction from hyalinising trabecular tumor have been discussed.
Cytological appearance in paraganglioma resembles MC. Clinical and radiological findings may not be of use in rare cases of intrathyroidal paraganglioma.42 Besides, a paraganglioma-like variant of MC has been described42 with FNA cytological appearances.221 Immunoreactivity to a panel of pan-endocrine markers as well as calcitonin and cytokeratin are required to distinguish this from paraganglioma (possible only on cell blocks).
Amyloid may be seen in smears from amyloid goiters as well as in plasmacytoma of thyroid.42 Attention to the morphology of the accompanying cells facilitates the diagnosis.
C-cell hyperplasia
The finding of calcitonin-positive C-cells in the absence of a discrete nodule raises the possibility of diffuse C-cell hyperplasia. This requires further investigation since it may precede development of MC.222
Anaplastic carcinoma (Figs 6.58-6.63)42,67,213,223-225

Fig. 6.59 Anaplastic spindle cell carcinoma
Cluster of pleomorphic plump spindle cells resembling malignant fibrous histiocytoma; note intranuclear vacuoles (MGG, HP).

Fig. 6.60 Anaplastic carcinoma, squamous variant
Smear showing keratinizing malignant cells in a necrotic background (PAP, HP).

Fig. 6.61 Spindle and giant cell carcinoma
Histiocyte-like giant cells; fibroblastoid spindle cells (Pap, HP).

Fig. 6.62 Anaplastic carcinoma with osteoclast-like giant cells
Malignant cells of spindle cell type and a multinucleated histiocytic osteoclast-like giant cell (HE, HP).

Fig. 6.63 Anaplastic carcinoma, inflammatory type
Many clustering polymorphs obscuring scattered single malignant epithelial cells (Pap, HP).
The most aggressive of all thyroid cancers, AC presents usually in women above 60 years of age as a rapidly growing, locally infiltrative, hard mass, associated with compression signs. Three major patterns or combinations of these patterns are seen, namely giant cell, spindle cell and squamoid patterns with large intervening areas of necrosis and hemorrhage.
Smears from AC may be cellular or paucicellular, depending on the amount of necrosis and the site of sampling. A malignant background diathesis of necrotic material and neutrophils is often present. Cells are extremely variable in shape and a mixture of spindle and giant cells are seen in about half of the cases. Cells show bizarre nuclei with macronucleoli, irregular nuclear membranes and coarsely clumped chromatin. INCIs may be present (Fig 6.59) in a fairly high proportion of cells, as in PC. Mitoses are numerous with abnormal forms. Keratinizing squamous cells may be present and are the dominating population in the squamous variant (Fig 6.60). Osteoclastic giant cells (Fig 6.62), chondroblastomatous, or osteoblastic differentiation may be seen.42,226,227 Bizarre cell morphology, the presence of necrosis and mitotic activity and a clinical history of a rapidly enlarging mass clinch the diagnosis. This in turn permits palliative treatment without operative intervention. Smears may show evidence of residual differentiated papillary or follicular cancer. Previous reports of small cell type of AC are in all probability examples of small cell type of MC, lymphoma or poorly differentiated thyroid carcinoma.
Necrosis, fibrosis and inflammation may dominate the cytological picture, obscuring diagnostic cells (Fig 6.63). Diagnostic reliability in AC is limited mainly by the sampling technique. The false-negative cytologic rate can be as high as 12% and is mainly due to non-representative sampling.42 In order to ensure adequate sampling, large tumor masses should be subjected to at least 3–4 needle passes at different sites, concentrating on firm areas of the lesion. Paucicellular variants of AC are difficult to diagnose on cytology225 and may mimic Riedel’s thyroiditis.42
The spindle cell variant of AC (Fig. 6.59) may be indistinguishable from spindle cell sarcomas. Immunostaining for cytokeratin, if positive, supports a diagnosis of AC. However, cytokeratin positivity is not always present and it may be focal (personal observation). Lack of thyroglobulin immunostaining helps distinguish it from poorly differentiated foci of differentiated thyroid carcinoma.
AC may contain remnants of pre-existing follicular or papillary neoplasms.42 If the needle has only sampled the differentiated component, the diagnosis of AC can be missed. Presence of INCIs in AC (Fig. 6.59) may cause confusion with high-grade PC. Grossly abnormal nuclear chromatin, tumor necrosis, mitotic activity and loss of expression of thyroglobulin suggest AC. MC of giant cell type may resemble AC cytologically; immunostaining for calcitonin and CEA are required.
Laryngeal carcinoma can occasionally extend and infiltrate the thyroid. If smears show a dominant squamoid pattern, a laryngoscopic examination is recommended to rule out a primary laryngeal carcinoma.
Giant cell carcinomas of pancreas and lung,90 sarcomatoid renal cell carcinoma and spindle cell melanomas may metastasize to thyroid and simulate giant cell or spindle cell types of AC, respectively. The value of correlating the cytologic picture with the clinical profile and relevant investigations cannot be overestimated.
Mitotically active, atypical reactive myofibroblasts are occasionally seen in thyroiditis and NG.90 Follicular cells undergoing repair may show nuclear aytpia with macronucleoli. Radioactive iodine and neomercazole treatment for GD leads to follicular atypia (see Fig. 6.8B). Careful history taking and thorough clinical assessment reduce diagnostic errors in most cases.
Lymphoma (Figs 6.64, 6.65)90,228,229
Lymphoma may involve the thyroid secondarily. Primary thyroid lymphoma is rare (1–5% of thyroid malignancies).230 Most are of B-cell lineage, of MALT type and often occur in a background of HT.42

Fig. 6.64 Malignant lymphoma, high grade
Highly cellular smear of predominantly large blastic lymphoid cells; note cluster of pale residual follicular epithelial cells (MGG, IP).

Fig. 6.65 Malignant lymphoma, low grade, in Hashimoto’s disease
The two figures are from the same case. (A) Mixed population of abnormal lymphoid cells, the majority are centrocyte-like; (B) Thyroiditis pattern of mixed lymphoid cells and a cluster of oxyphil epithelial cells (MGG, IP).
High-grade lymphomas show a dispersed population of predominantly large abnormal lymphoid cells of blastic type (Fig. 6.64). Patients are usually elderly females presenting with rapid thyroid enlargement and pressure symptoms, clinically mimicking AC. Low-grade lymphomas, especially with coexistent HT, present a diagnostic problem, as discussed earlier. A mixed cell population including plasma cells, suggestive of a florid reactive process, may be seen in smears of low-grade lymphoma. Diagnostic difficulties are enhanced by the presence of residual reactive follicles in low-grade MALT lymphoma. Primary thyroid involvement by Hodgkin’s disease is rare but has been documented.42
Distinction of low-grade lymphomas from HT is difficult and requires flow cytometry and immunocytochemical demonstration of monoclonality.228 Situations where both diseases coexist are further complicated by sampling problems. Selective needling of the recently enlarging nodule often yields diagnostic samples. General principles guiding the distinction of non-Hodgkin’s lymphoma from reactive lymphoid infiltrates are covered in Chapter 5.
Apart from the rare small cell variant of MC, true anaplastic small cell carcinoma is extremely rare. Round fragments of pale blue cytoplasm in the background (lymphoglandular bodies) favor lymphoma, while cell clustering, nuclear molding and tear-drop cells favor small cell AC. Metastatic small cell carcinoma should be excluded. Immunostaining is indispensable.
Langerhans cell histiocytosis rarely involves the thyroid as a part of multiorgan disease231 and may be mistaken cytologically for lymphoma. Admixture with eosinophils and multinucleate giant cells, indentation of nuclei, dendrite-like cytoplasmic processes and positive staining with S-100 protein are clues to the diagnosis.
Uncommon malignancies of thyroid
Mucoepidermoid carcinoma of thyroid can be rarely encountered on FNA where it is usually diagnosed as poorly differentiated carcinoma.232,233 Brief reports of the cytology of angiosarcoma and Kaposi’s sarcoma of thyroid, hemangioendothelioma, osteosarcoma, and metastatic sarcoma are present in the literature.42,234-236 Teratomas237,238 occur rarely in the thyroid and are mainly seen in infants or children where they are usually benign.42 A few teratomas reported in adults were malignant, with the tumor showing a prominent primitive neuroepithelial component. FNA smears in an aggressive and rapidly fatal tumor in a young female238 showed features suggestive of primitive neuroectodermal tumor with frequent neuroblastoma-like rosettes. Histology of the resected tumor showed neural tubules and neurites, squamous and glandular epithelium with nodal metastasis showing a neuroepithelial pattern.
Metastatic malignancies (Figs 6.29, 6.66 and 6.67)42
Metastasis to the thyroid is usually a terminal event in disseminated malignancies, questioning the rationale of conventional treatment. Cytology is very useful in determining whether the lesion in a known case of cancer is a metastasis, a thyroid primary or a non-neoplastic thyroid lesion. Rarely, thyroid metastases may be the presenting feature of an otherwise occult primary (such as renal cell carcinoma).42 A metastatic tumor can clinically simulate a primary neoplasm or even thyroiditis.112 Lung, gastrointestinal tract (Fig. 6.66), breast (see Fig. 6.29), kidney, melanoma and lymphoma are the most frequent sites of origin. Breast carcinoma may resemble and be misinterpreted as poorly differentiated follicular carcinoma of thyroid (Fig. 6.67), and the importance of clinical notes cannot be overemphasized. When cytological features are at variance with those seen in primary thyroid cancers, it is a good policy to meticulously go through the clinical notes for any record of other previous primary cancers and to request cytology and histopathology slides of the case for review.

Fig. 6.66 Metastatic carcinoma from large bowel
Note microglandular structures, columnar cells and necrotic debris (MGG, HP).


Fig. 6.67 Metastatic breast and thyroid carcinoma, overlapping cytological features
(A) Smear from breast carcinoma metastatic to thyroid (MGG, HP); (B) Smear from follicular carcinoma metastatic to clavicle (MGG, HP).
Based on cytomorphologic pattern the following possibilities may be considered and clinical details and relevant ancillary stains used for their distinction:
Clear cell morphology: Metastasis from renal cell carcinoma, salivary gland carcinoma, clear cell melanoma, thyroid and parathyroid tumors showing clear cell change.
Papillary morphology: PC of thyroid, breast carcinoma, rare cases of melanoma.239
Oncocytic cells: HCT, oncocytic variants of PC and MC, renal cell carcinoma, salivary gland carcinoma.
Small round cells: Lymphoma, small cell variant of MC, poorly differentiated thyroid carcinoma, metastatic small cell carcinoma, malignant teratoma.
Mucin producing cells: Colonic and lung carcinomas, salivary gland carcinoma, rare mucin-producing variant of MC.
Squamous morphology: AC, laryngeal and lung carcinoma.
Spindle cell morphology: MC, AC, primary and metastatic spindle cell sarcomas, melanoma, sarcomatoid renal, pancreatic and lung carcinomas, atypical reactive myofibroblasts.
Pleomorphic multinucleate giant cells: AC, metastatic pleomorphic sarcomas and giant cell carcinomas of pancreas and lung.
Parathyroid neoplasms (Figs 6.68 and 6.69)136,240-242
Parathyroid neoplasms and cysts have been discussed briefly in the earlier section. Cytology is of limited value in the preoperative assessment of patients with hyperparathyroidism. If a parathyroid adenoma cannot be located by surgery, cytology in conjunction with US examination of the neck or mediastinal CT can be tried. High cellularity, aggregates of cohesive cells with small nuclei 6–8 µm in diameter, coarse granular chromatin, some larger nuclei 10–30 µm, numerous bare nuclei, scattered oxyphil cells and absence of colloid or macrophages indicate parathyroid tissue.240,242,244 Papillae and INCIs (Fig 6.69) have been noted.243,245 Monolayered sheets and microfollicular structures suggest thyroid origin,243 but have been seen in parathyroid adenoma (Fig. 6.68); it is agreed that no single cytologic feature can definitely distinguish parathyroid from thyroid follicular nodules.
1 Söderstrom N. Puncture of goiters for aspiration biopsy. A preliminary report. Acta Med Scand. 1952;144:235-244.
2 Einhorn J, Franzén S. Thin-needle biopsy in the diagnosis of thyroid disease. Acta Radiol. 1962;58:321-336.
3 Kini SR. Thyroid. In Kline TS, editor: Guides to clinical aspiration biopsy, 2nd ed, New York: Igaku-Shoin, 1996.
4 Ashcroft MW, van Herle AJ. Management of thyroid nodules II. Head Neck Surg. 1981;3:297-322.
5 Löwhagen T, Granberg PO, Lundell G, et al. Aspiration biopsy cytology (ABC) in nodules of the thyroid gland suspected to be malignant. Surg Clin North Am. 1979;59:3-18.
6 Cramer H. Fine-needle aspiration of the thyroid. An appraisal. Cancer (Cancer Cytopathol). 2000;90:325-329.
7 Ashcroft MW, van Herle AJ. Management of thyroid nodules. I. Head. Neck Surg. 1981;3:216-230.
8 Layfield LJ, Cibas ES, Gharib H, Mandel SJ. Thyroid aspiration cytology: current status. CA Cancer J Clin. 2009;59:99-110.
9 Khalid AN, Hollenbeak CS, Quraishi SA, et al. The cost-effectiveness of iodine 131 scintigraphy, ultrasonography, and fine-needle aspiration biopsy in the initial diagnosis of solitary thyroid nodules. Arch Otolaryngol Head Neck Surg. 2006;132:244-250.
10 Yang J, Schnadiq V, Logrono R, Wasseman PG. Fine-needle aspiration of thyroid nodules: a study of 4703 patients with histological and clinical correlations. Cancer. 2007;111:306-315.
11 Ravetto C, Colombo L, Dottorini ME. Usefulness of fine-needle aspiration in the diagnosis of thyroid carcinoma. A retrospective study in 37,895 patients. Cancer (Cancer Cytopathol). 2000;90:357-363.
12 Sangalli G, Serio G, Zampatti C, et al. Fine needle aspiration cytology of the thyroid: a comparison of 5469 cytological and final histological diagnoses. Cytopathology. 2006;17:245-250.
13 Schmid KW, Ladurner D, Zechmann W, et al. Clinicopathologic management of tumours of the thyroid gland in an endemic goitre area. Combined use of preoperative fine needle aspiration biopsy and intraoperative frozen section. Acta Cytol. 1989;33:27-30.
14 Muruganandham K, Sistla SC, Elangovan S, et al. Routine ultrasound-guided aspiration cytology for evaluation of palpable thyroid nodules in an endemic area: is it justified? J Otolaryngol Head Neck Surg. 2009;38:222-226.
15 Nabriski D, Ness-Abramof R, Brosh TO, et al. Clinical relevance of non-palpable thyroid nodules as assessed by ultrasound-guided fine needle aspiration biopsy. J Endocrinol Invest. 2003;26:3-4.
16 AACE/AME task force on thyroid nodules. American association of clinical endocrinologists and Associazione Medici Endocrinologi medical guidelines for clinical practice for the diagnosis and management of thyroid nodules. Endocr Pract. 2006;12:63-102.
17 Cesur M, Corapcioglu D, Bulut S, et al. Comparison of palpation-guided fine needle aspiration biopsy to ultrasound guided fine-nedle aspiration biopsy in the evaluation of thyroid nodules. Thyroid. 2006;16:555-561.
18 Dobrinja C, Trevisian G, Ligouri G, et al. Sensitivity evaluation of fine needle aspiration cytology in thyroid lesions. Diagn Cytopathol. 2009;37:230-235.
19 Screaton NJ, Berman LH, Grant JW. US-guided core-needle biopsy of the thyroid gland. Radiology. 2003;226:827-832.
20 Renshaw AA, Pinnar N. Comparison of thyroid fine-needle aspiration and core needle biopsy. Am J Clin Pathol. 2007;128:370-374.
21 Yang GC, Liebeskind D, Messina AV. Should cytopathologists stop reporting follicular neoplasms on fine-needle aspiration of the thyroid? Diagnosis and histologic follow-up of 147 cases. Cancer (Cancer Cytopathol). 2003;99:69-74.
22 De May RM. Follicular lesions of the thyroid. W(h)ither follicular carcinoma? Am J Clin Pathol. 2000;114:681-683.
23 Kini SR, Miller JM, Hamburger JI, Smith-Purslowe MJ, et al. Cytopathology of follicular lesions of the thyroid gland. Diagn Cytopathol. 1985;1:123-132.
24 LiVolsi VA, Asa SL. The demise of follicular carcinoma of the thyroid gland. Thyroid. 1994;4:233-236.
25 Abati A. The National Cancer Institute Thyroid FNA State of the Science Conference: ‘Wrapped up’. Diagn Cytopathol. 2008;36:388-389.
26 Bibbo M. Thyroid fine needle aspiration. Aca Cytol. 2009;53:489-490.
27 Hall TL, Layfield LJ, Philippe A, et al. Sources of diagnostic error in fine needle aspiration of the thyroid. Cancer. 1989;63:718-725.
28 Silverman JF, West RL, Larkin EW, et al. The role of fine needle aspiration biopsy in the rapid diagnosis and management of thyroid neoplasm. Cancer. 1986;57:1164-1170.
29 La Rosa GL, Belfiore A, Giuffrida D, et al. Evaluation of the fine needle aspiration biopsy in the preoperative selection of cold thyroid nodules. Cancer. 1991;67:2137-2141.
30 Hsu C, Boey J. Diagnostic pitfalls in the fine needle aspiration of thyroid nodules. A study of 555 cases in Chinese patients. Acta Cytol. 1987;31:699-704.
31 Sarda AK, Bal S, Dutta Gupta S, et al. Diagnosis and treatment of cystic disease of the thyroid by aspiration. Surgery. 1988;103:593-596.
32 Hor T, Lahiri SW. Bilateral thyroid hematomas after fine-needle aspiration causing acute airway obstruction. Thyroid. 2008;18:567-569.
33 Park MH, Yoon JH. Anterior neck hematoma causing airway compression following fine needle aspiration cytology of the thyroid nodule; a case report. Acta Cytol. 2009;53:86-88.
34 Anastasilakis AD, Polyzos SA, Nikolopoulos P. Subendothelial carotid hematoma after fine-needle aspiration biopsy of a solitary thyroid nodule. J Ultrasound Med. 2008;27:1517-1520.
35 Alkan S, Kosar AT, Erdurak SC, et al. Transient vocal cord paralysis following ultrasound-guided fine needle aspiratin biopsy for a thyroid nodule. J Otolaryngol Head Neck Surg. 2009;38:E14-E15.
36 Van den Bruel A, Roelandt P, Drijkoningen M, et al. A thyroid thriller: acute transient and symmetric goiter after fine-neelde aspiration of a solitary thyroid nodule. Thyroid. 2008;18:81-84.
37 Nishihara E, Miyauchi A, Matsuzuka F, et al. Acute suppurative thyroiditis after fine-needle aspiration causing thyrotoxicosis. Thyroid. 2005;15:1183-1187.
38 Musharrefieh UM, Nasrallah MP, et al. Chemical neuritis after fine needle aspiration biopsy of thyroid nodule. J Endocrinol Invest. 2006;29:947-948.
39 Das DK, Janardan C, Pathan SK, et al. Infarction in a thyroid nodule after fine needle aspiration. Report of 2 cases with a discussion of the cause of pitfalls in the histopatholgoical diagnosis of papillary thyroid carcinoma. Acta Cytol. 2009;53:571-575.
40 Bolat F, Kayaselcuk F, Nursal TZ, et al. Histopathological changes in thyroid tissue after fine needle aspiration biopsy. Pathol Res Pract. 2007;203:641-645.
41 Sharma C, Krishnanand G. Histologic analysis and comparison of techniques in fine needle aspiration-induced alterations in thyroid. Acta Cytol. 2008;52:56-64.
42 Jayaram G. Atlas and text of thyroid cytology. New Delhi: Arya Publications; 2006.
43 Karwowski JK, Nowels KW, McDougall IR, et al. Needle track seeding of papillary thyroid carcinoma from fine needle aspiration biopsy. A case report. Acta Cytol. 2002;46:591-595.
44 Tamiolakis D, Antoniou C, Venizelos J, et al. Papillary thyroid carcinoma metastasis most probably due to fine needle aspiration biopsy. A case report. Acta Dermatovenerol Alp Panonica Adriat. 2008;15:169-172.
45 Uchida N, Suda T, Inoue T, et al. Needle track disseminatin of follicular thyroid carcinoma following fine-needle aspiration biopsy: report of a case. Surg Today. 2007;37:34-37.
46 Zhu W, Michael CW. How important is on-site adequacy assessment for thyroid FNA? An evaluation of 883 cases. Diagn Cytopathol. 2007;35:183-186.
47 Layfield LJ, Bentz JS, Gopez EV. Immediate on-site interpretation of fine-needle aspiration smears. A cost and compensation analysis. Cancer. 2001;93:319-322.
48 Baloch ZW, Tam D, Langer J, et al. Ultrasound-guided fine-needle aspiration biopsy of the thyroid: role of on-site assessment and multiple cytological preparations. Diagn Cytopathol. 2000;23:425-429.
49 Rosen IB, Azadian A, Walfish PG, et al. Ultrasound-guided fine-needle aspiration biopsy in the management of thyroid disease. Am J Surg. 1993;166:346-349.
50 Qiu L, Crapanzano JP, Saqi A, et al. Cell block alone as an ideal preparatory method for hemorrhagic thyroid nodule aspirates procured without onsite cytologists. Acta Cytol. 2008;52:139-144.
51 Stamataki M, Anninos D, Brountzos E, et al. The role of liquid-based cytology in the investigation of thyroid lesions. Cytopathology. 2008;19:11-18.
52 Ljung BM. Thyroid fine-needle aspiration: smears versus liquid-based preparations. Cancer. 2008;114:144-148.
53 Kato MA, Fahey TJ3rd. Molecular markers in thyroid cancer diagnostics. Surg Clin North Am. 2009;89:1139-1155.
54 Maruta J, Hashimoto H, Yamashita H, et al. Immunostaining of galectin-3 and CD44v6 using fine-needle aspiration for distinguishing follicular carcinoma from adenoma. Diagn Cytopathol. 2004;31:392-396.
55 Penelli G, Mian C, Pelizzo MR, et al. Galectin-3 cytotest in thyroid follicular neoplasia. A prospective, monoinstitutional study. Acta Cytol. 2009;53:533-539.
56 Collet JF, Hurbain I, Prengel C, et al. Galectin-3 immunodetection in follicular thyroid neoplasms: a prospective study on fine-needle aspiration samples. Br J Cancer. 2005;93:1175-1181.
57 Christensen L, Bilchert-Toft M, Brandt M, et al. Thyroperoxidase (TPO) immunostaining of the solitary cold thyroid nodule. Clin Endocrinol. 2000;53:161-169.
58 Lerma E, Mora J. Telomerase activity in ‘suspicious’ thyroid cytology. Cancer. 2005;105:492-497.
59 Lubitz CC, Ugras SK, Kazam JJ, et al. Microarray analysis of thyroid nodule fine-needle aspirates accurately classifies benign and malignant lesions. J Mol Diagn. 2006;8:490-498.
60 Troncone G, Volante M, Iaccarino A, et al. Cyclin D1 and D3 overexpression predicts malignant behavior in thyroid fine-needle aspirates suspicious for Hurthle cell neoplasms. Cancer Cytopathol. 2009;117:522-529.
61 Boon ME, Löwhagen T, Cardozo PL, et al. Computation of preoperative diagnosis probability for follicular adenoma and carcinoma of the thyroid on aspiration smears. Anal Quant Cytol. 1982;4:1-5.
62 La Rosa GL, Cavallari V, Giuffrida D, et al. The morphometric analysis of all nuclei from fine needle aspirates of thyroid follicular cells does not improve the diagnostic accuracy of traditional cytological examination. J Endocrinol Invest. 1990;13:701-707.
63 Solymosi T, Tóth V, Sápi Z, et al. Diagnostic value of AgNOR method in thyroid cytopathology: correlation with morphometric measurements. Diagn Cytopathol. 1996;14:140-144.
64 Bäckdahl M, Wallin G, Lowhagen T, et al. Fine needle biopsy cytology and DNA analysis. Their place in the evaluation and treatment of patients with thyroid neoplasms. Surg Clin North Am. 1987;67:197-211.
65 Raab SS, Vrbin CM, Grzybicki DM, et al. Errors in thyroid gland fine needle aspriration. Am J Clin Pathol. 2006;125:873-882.
66 Hamburger JI, Husain M, Nishiyama R, et al. Increasing the accuracy of fine needle biopsy for thyroid nodules. Arch Pathol Lab Med. 1989;113:1035-1041.
67 Droese M. Cytological aspiration biopsy of the thyroid gland, 2nd ed. Stuttgart: Schattauer; 1995.
68 Suen KC. How does one separate cellular follicular lesions of the thyroid by fine needle aspiration biopsy? Diagn Cytopathol. 1988;4:78-81.
69 Nassar A, Gupta P, LiVolsi VA, et al. Histiocytic aggregates in benign nodular goitres mimicking cytologic features of papillary thyroid carcinoma (PTC). Diagn Cytopathol. 2003;29:243-245.
70 Gul K, Di Ri Doc A, Ki Yak G, et al. Thyroid carcinoma risk in patients with hyperthyroidism and role of preoperative cytology in diagnosis. Minerva Endocrinol. 2009;34:281-288.
71 Jayaram G, Kaur A. Cystic thyroid nodules harbouring malignancy. A problem in fine needle aspiration cytodiagnosis. Acta Cytol. 1989;33:941-942.
72 Hamburger JI, Hamburger SW. Fine needle biopsy of thyroid nodules: avoiding the pitfalls. NY State J Med. 1986;86:241-249.
73 Jaragh M, Carvdis VB, MacMillan C, et al. Predictors of malignancy in thyroid fine-needle aspirates ‘cyst fluid only’ cases; can potential clues of malignancy be identified? Cancer Cytopathol. 2009;117:305-310.
74 Caraway NP, Sneige N, Samaan NA. Diagnostic pitfalls in thyroid fine-needle aspiration: a review of 394 cases. Diagn Cytopathol. 1993;9:345-349.
75 Shahin A, Burroughs FH, Kirby JP, et al. Thyroglossal duct cyst: a cytopathologic study of 26 cases. Diagn Cytopathol. 2005;33:365-369.
76 Dim DC, Riveros-Angel M, Wong-You-Cheong J, et al. Ultrasound guided fine needle aspiration cytology diagnosis of a foregut cyst in the thyroid. A case report. Acta Cytol. 2009.
77 Chen KT. Fine-needle aspiration cytology of epidermoid cyst of the thyroid: report of a case and review of seven cases. Diagn Cytopathol. 2007;35:123-124.
78 Lerud KS, Tabbara SO, Del Vecchio DM, et al. Cytomorphology of cystic parathyroid lesions: report of four cases evaluated preoperatively by fine-needle aspiration. Diagn Cytopathol. 1996;15:306-311.
79 Paes JE, Burman KD, Cohen J, et al. Acute bacterial suppurative thyroiditis: a clinical review and expert opinion. Thyroid. 2010;20:247-255.
80 Trbojevic B, Djurica S. Diagnosis of autoimmune thyroid disease. Srp Arh Celok Lek. 2005;133(Suppl. 1)):25-33.
81 Persson PS. Cytodiagnosis of thyroiditis. A comparative study of cytological, histological, immunological and clinical findings in thyroiditis. Acta Med Scand. 1968;483(Suppl.):7-100.
82 Jayaram G, Singh B, Marwaha RK. Graves’ disease. Appearance in cytologic smears from fine needle aspirates of the thyroid gland. Acta Cytol. 1989;33:36-40.
83 Volavsek M, Us-Krasovec M, Auersperg M, et al. Marginal vacuoles in fine-needle aspirates of follicular thyroid carcinoma. Diagn Cytopathol. 1996;15:93-97.
84 Das DK, Jain S, Tripathi KP, et al. Marginal vacuoles in thyroid aspirates. Acta Cytol. 1998;42:1121-1128.
85 Sturgis CD. Radioactive iodine-associated cytomorphologic alterations in thyroid follicular epithelium: is recognition possible in fine-needle aspiration specimens? Diagn Cytopathol. 1999;21:207-210.
86 Gutteridge DH, Orell SR. Non-toxic goitre: diagnostic role of aspiration cytology, antibodies and serum thyrotrophin. Clin Endocrinol. 1978;9:505-514.
87 Jayaram G, Marwaha RK, Gupta RK, et al. Cytomorphologic aspects of thyroiditis. A study of 51 cases with functional, immunologic and ultrasonographic data. Acta Cytol. 1987;31:687-693.
88 Poropatich C, Marcus D, Oertel YC. Hashimoto’s thyroiditis: fine-needle aspirations of 50 asymptomatic cases. Diagn Cytopathol. 1994;11:141-145.
88A Singh A, Kahlon SK, Chahal KS, et al. Hashimoto’s thyroiditis – an unusual presentation as cystic solitary nodule – a diagnostic dilemma. J Cytol. 2003;20(4):193-195.
89 Nguyen G-K, Ginsberg J, Crockford PM, et al. Hashimoto’s thyroiditis: cytodiagnostic accuracy and pitfalls. Diagn Cytopathol. 1997;16:531-536.
90 De May RM. The art and science of cytopathology-Vol II- aspiration cytology. Chicago: ASCP Press; 1996.
91 Roasai Juan, editor. Rosai and Ackerman’s Surgical Pathoogy, 9th ed, St. Louis. MO: Mosby, 2004.
92 Okayasu I, Hatakeyama S, Tanaka Y, et al. Is focal chronic autoimmune thyroiditis an age-related disease? Differences in incidence and severity between Japanese and British. J Pathol. 1991;163:257-264.
93 Jayaram G, Iyengar KR, Sthaneshwar P, et al. Hashimoto’s thyroiditis; a Malaysian perspective. J Cytology. 2007;24:119-124.
94 Singh N, Kumar S, Negi VS, et al. Cytomorphologic study of Hashimoto’s thyroiditis and its serologic correlation. A study of 150 cases. Acta Cytol. 2009;53:507-516.
95 Kumarasinghe MP. Cytomorphologic features of diffuse sclerosing variant of papillary carcinoma of the thyroid. A report of two cases in children. Acta Cytol. 1998;42:983-986.
96 Yousef O, Dichard A, Bocklage T. Aspiration cytology features of the Warthin tumour-like variant of papillary thyroid carcinoma. A report of two cases. Acta Cytol. 1997;41:1361-1368.
97 Zeppa P, Cossolino I, Peluso AL, et al. Cytologic, flow cytometry and molecular assessment of lymphoid infiltrate in fine-needle cytology samples of Hashimoto thyroiditis. Cancer Cytopathol. 2009;117:174-184.
98 Kini SR, Miller JM, Hamburger JI. Cytopathology of Hurthle cell lesions of the thyroid gland by fine needle aspiration. Acta Cytol. 1981;25:647-652.
99 Gonzalez JL, Wang HH, Ducatman BS. Fine-needle aspiration of Hurthle cell lesions. A cytomorphologic approach to diagnosis. Am J Clin Pathol. 1993;100:231-235.
100 Ravinsky E, Safneck JR. Differentiation of Hashimoto’s thyroiditis from thyroid neoplasm in fine needle aspirates. Acta Cytol. 1988;32:854-861.
101 Kollur SM, El Sayed S, El Hag A. Follicular thyroid lesions coexisting with Hashimoto’s thyroiditis: incidence and possible sources of diagnostic errors. Diagn Cytopathol. 2003;28:35-38.
102 McDonald L, Yadzi HM. Fine needle aspiration biopsy of Hashimoto’s thyroiditis. Sources of diagnostic error. Acta Cytol. 1999;43:400-406.
103 Carson HJ, Castelli MJ, Gattuso P. Incidence of neoplasia in Hashimoto’s thyroiditis. A fine-needle aspiration study. Diagn Cytopathol. 1996;14:38-42.
104 Friedman M, Shimaoka K, Rao U, et al. Diagnosis of chronic lymphocytic thyroiditis (nodular presentation) by needle aspiration. Acta Cytol. 1981;25:513-522.
105 Kini SR, Miller JM, Hamburger JI. Problems in the cytologic diagnosis of the ‘cold’ thyroid nodule in patients with lymphocytic thyroiditis. Acta Cytol. 1981;25:506-512.
106 Bhalotra R, Jayaram G. Overlapping morphology in thyroiditis (Hashimoto’s and subacute) and Grave’s disease. Cytopathology. 1990;1:371-372.
107 Harigopal M, Sahoo S, Recant WM, et al. Fine-needle aspiration of Riedel’s disease: report of a case and review of the literature. Diagn Cytopathol. 2004;30:193-197.
108 Dugan JM, Atkinson BF, Avitabile A, et al. Psammoma bodies in fine needle aspirate of the thyroid in lymphocytic thyroiditis. Acta Cytol. 1987;31:330-334.
109 Cipolla C, Sandonato L, Graceffa G, et al. Hashimoto thyroiditis coexistent with papillary thyroid carcinoma. Am Surg. 2005;71:874-878.
110 Sidaway MK, Costa M. The significance of paravacuolar granules of the thyroid. A histologic, cytologic and ultrastructural study. Acta Cytol. 1989;33:929-934.
111 Shabb NS, Tawil A, Gergeos F, et al. Multinucleated giant cells in fine-needle aspiration of thyroid nodules: their diagnostic significance. Diagn Cytopathol. 1999;21:307-312.
112 Rosen IB, Strawbridge HG, Walfish PG, et al. Malignant pseudothyroiditis: a new clinical entity. Am J Surg. 1978;136:445-449.
113 Prakash R, Jayaram G, Singh RP. Follicular thyroid carcinoma masquerading as subacute thyroiditis diagnosis using ultrasonography and radionuclide thyroid angiography. Australas Radiol. 1991;35:174-177.
114 Carney JA, Moore SB, Northcutt RC, et al. Palpation thyroiditis (multifocal granulomatous folliculitis). Am J Clin Pathol. 1975;64:639-647.
115 Shigemasa C, Kouchi T, Taniguchi S, et al. Autoimmune thyroiditis with transient thyrotoxicosis: comparison between painful thyroiditis and painless thyroiditis. Horm Res. 1991;36:9-15.
116 Mizukami Y, Michigishi T, Hashimoto T, et al. Silent thyroiditis: A histologic and immunohistochemical study. Hum Pathol. 1988;19:423-431.
117 Atkinson B, Ernest CS, Li Volsi V. Cytologic diagnosis of follicular tumours of the thyroid. Diagn Cytopathol. 1986;2:1-5.
118 Baloch ZW, Fleisher S, LiVolsi VA, et al. Diagnosis of ‘follicular neoplasm’: A gray zone in thyroid fine needle aspiration cytology. Diagn Cytopathol. 2002;26:41-44.
119 Harach HR. Usefulness of fine needle aspiration of the thyroid in an endemic goitre region. Acta Cytol. 1989;33:31-35.
120 Busseniers AE, Oertel YC. Cellular adenomatoid nodules of the thyroid: review of 219 fine-needle aspirates. Diagn Cytopathol. 1993;9:581-589.
121 Kapur U, Wojcik EM. Follicular neoplasm of the thyroid-vanishing cytologic diagnosis? Diagn Cytopathol. 2007;35:525-528.
122 Jaffar R, Mohanty SK, Khan A, et al. Hemosiderin laden macrophages and hemosiderin within follicular cells distinguish benign follicular lesions from follicular neoplasms. Cytojournal. 2009;6:3.
123 Cusick EL, MacIntosh CA, Krukowski ZH, et al. Management of isolated thyroid swellings: a prospective six year study of fine needle aspiration cytology in diagnosis. Br Med J. 1990;301:318-321.
124 Boon ME, Lowhagen T, Willems JS. Planimetric studies on fine needle aspirates from follicular adenomas and follicular carcinomas of the thyroid. Acta Cytol. 1980;24:145-148.
125 Nunez C, Mendelsohn G. Fine needle aspiration and needle biopsy of the thyroid gland. Pathol Annu. 1989;24(Pt 1):161-198.
126 Kumar VK, Abbas AK, Fausto N. Robbins and Cotran Pathologic basis of disease, 7th ed. Philadelphia, PA: Elsevier Saunders; 2005.
127 Marhefka GD, McDivitt JD, Mohamed Shakir KM, et al. Diagnosis of follicular neoplasm in thyroid nodules by fine needle aspiration cytology. Does the result, benign vs. suspicious for a malignant process, in these nodules make a difference? Acta Cytol. 2009;53:517-523.
128 Frasoldati A, Flora M, Pesenti M, et al. Computer-assisted cell morphometry and ploidy analysis in the assessment of thyroid follicular neoplasms. Thyroid. 2001;11:941-946.
129 Camargo RS, Shirata NK, di Loreto C, et al. Significance of AgNOR measurement in thyroid lesions. Anal Quant Cytol Histol. 2006;28:188-192.
130 King AD, Yeung DK, Ahuja AT, et al. In vivo IH MR spectroscopy of thyroid carcinoma. Eur J Radiol. 2005;54:112-117.
131 Baloch ZW, LiVolsi VA. Fine-needle aspiration of the thyroid: today and tomorrow. Best Pract Res Clin Endocrinol Metab. 2008;22:929-939.
132 Clark OH. Predictors of thyroid tumor aggressiveness. West J Med. 1996;165:156-157.
133 Mihai R, Parker AJ, Roskell D, et al. One in four patients with follicular thyroid cytology (THY3) has a thyroid carcinoma. Thyroid. 2009;19:33-37.
134 Das DK, Mallik MK, Sharma P, et al. Papillary thyroid carcinoma and its variants in fine needle aspiration smears. A cytomorphologic study with special reference to tall cell variant. Acta Cytol. 2004;48:325-336.
135 Yang GC, Liebeskind D, Messina AV. Diagnostic accuracy of follicular variant of papillary thyroid carcinoma in fine-needle aspirates processed by ultrafast Papanicolaou stain: histologic follow-up of 125 cases. Cancer. 2006;108:174-179.
136 Bondeson L, Bondeson AG, Nissborg A, et al. Cytopathological variables in parathyroid lesions: a study based on 1,600 cases of hyperparathyroidism. Diagn Cytopathol. 1997;16:476-482.
137 Agarwal AM, Bentz JS, Hungerford R, et al. Parathyroid fine-needle aspiration cytology in the evaluation of parathyroid adenoma: cytologic findings from 53 patients. Diagn Cytopathol. 2009;37:407-410.
138 Odashiro AN, Nguyen GK. Fine-needle aspiration cytology of an intrathyroid parathyroid adenoma. Diagn Cytopathol. 2006;34:790-792.
139 Chang TC, Tung CC, Hsiao YL, et al. Immunoperoxidase staining in the differential diagnosis of parathyroid from thyroid origin in fine needle aspirates of suspected parathyroid lesions. Acta Cytol. 1998;42:619-624.
140 Tseleni-Balafouta S, Gakiopoulou H, Kavantzas N, et al. Parathyroid proliferations: a source of diagnostic pitfalls in FNA of thyroid. Cancer. 2007;111:130-136.
141 Kwak JY, Kim EK, Moon HJ, et al. Parathyroid incidentalomas detected on routine ultrasound-directed fine-needle aspiration biopsy in patients referred for thyroid nodules and the role of parathyroid hormone analysis in the samples. Thyroid. 2009;19:743-748.
142 Cannizzaro M, Fiorenza G, Garofalo L, et al. [Hürthle-cell thyroid neoplasms: a clinical enigma. Ann Ital Chir. 1999;70:503-508. discussion 508–509
143 Mills SC, Haq M, Smellie WJ, et al. Hürthle cell carcinoma of the thyroid: Retrospective review of 62 patients treated at the Royal Marsden Hospital between 1946 and 2003. Eur J Surg Oncol. 2009;35:230-234.
144 Yaqub A. Familial Hurthle cell carcinoma of the thyroid: case reports and review of the literature. W V Med J. 2009;105:23-28.
145 Nguyen GK, Husain M, Akin MR. Cytodiagnosis of benign and malignant Hürthle cell lesions of the thyroid by fine-needle aspiration biopsy. Diagn Cytopathol. 1999;20:261-265.
146 Kaur A, Jayaram G. Thyroid tumors: cytomorphology of Hurthle cell tumors, including an uncommon papillary variant. Diagn Cytopathol. 1993;9:135-137.
147 Pambuccian SE, Becker RLJr, Ali SZ, et al. Differential diagnosis of Hurthle cell neoplasms on fine needle aspirates. Can we do any better with morphometry? Acta Cytol. 1997;41:197-208.
148 Volante M, Bozzalla-Cassione F, DePompa R, et al. Galectin-3 and HBME-1 expression in oncocytic cell tumors of the thyroid. Virchows Arch. 2004;445:183-188.
149 Jayaram G, Kakar A. Hurthle cell nodules of thyroid following irradiation: neoplastic or non-neoplastic? Ind J Radiol Imag. 1994;4:67-68.
150 el-Sahrigy D, Zhang XM, Elhosseiny A, et al. Signet-ring follicular adenoma of the thyroid diagnosed by fine needle aspiration. Report of a case with cytologic description. Acta Cytol. 2004;48:87-90.
151 Pietribiasi F, Sapino A, Papotti M, et al. Cytologic features of poorly differentiated ‘insular’ carcinoma of the thyroid, as revealed by fine-needle aspiration biopsy. Am J Clin Pathol. 1990;94:687-692.
152 Sironi M, Collini P, Cantaboni A. Fine needle aspiration cytology of insular thyroid carcinoma. A report of four cases. Acta Cytol. 1992;36:435-439.
153 Kuhel WI, Kutler DI, Santos-Buch CA. Poorly differentiated insular thyroid carcinoma. A case report with identification of intact insulae with fine needle aspiration biopsy. Acta Cytol. 1998;42:991-997.
154 Nguyen GK, Akin MRM. Cytopathology of insular carcinoma of thyroid. Diagn Cytopathol. 2001;25:325-330.
155 Layfield LJ, Gopez EV. Insular carcinoma of the thyroid. Report of a case with intact insulae and microfollicular structures. Diagn Cytopathol. 2000;23:409-413.
156 Volante M, Collini P, Nikiforov YE, et al. Poorly differentiated thyroid carcinoma: the Turin proposal for the use of uniform diagnostic criteria and an algorithmic diagnostic approach. Am J Surg Pathol. 2007;31:1256-1264.
157 Bongiovanni M, Sadow PM, Faquin WC. Poorly differentiated thyroid carcinoma: a cytologic-histologic review. Adv Anat Pathol. 2009;16:283-289.
158 Bongiovanni M, Bloom L, Krane JF, et al. Cytomorphologic features of poorly differentiated thyroid carcinoma: a multi-institutional analysis of 40 cases. Cancer Cytopathol. 2009;117:185-194.
159 Henderson YC, Shellenberger TD, Williams MD, et al. High rate of BRAF and RET/PTC dual mutations associated with recurrent papillary thyroid carcinoma. Clin Cancer Res. 2009;15:485-491.
160 Kini SR, Miller JM, Hamburger JI, et al. Cytopathology of papillary carcinoma of the thyroid by fine needle aspiration. Acta Cytol. 1980;24:511-521.
161 Miller TR, Bottles K, Holly EA, et al. A step-wise logistic regression analysis of papillary carcinoma of the thyroid. Acta Cytol. 1986;30:285-293.
162 Kaur A, Jayaram G. Thyroid tumors: Cytomorphology of papillary carcinoma. Diagn Cytopathol. 1991;7:462-468.
163 Szporn AH, Yuan S, Wu M, et al. Cellular swirls in fine needle aspirates of papillary thyroid carcinoma: a new diagnostic criterion. Mod Pathol. 2006;19:1470-1473.
164 Das DK, Sharma PN. Diagnosis of papillary thyroid carcinoma in fine needle aspiration smears. Factors that affect decision making. Acta Cytol. 2009;53:497-506.
165 Das DK, Sharma PN. Intranuclear cytoplasmic inclusions and nuclear grooves in fine needle aspiration smears of papillary thyroid carcinoma and its variants. Advantage of the count under an oil immersion objective over a high power objective. Analyt Quant Cytol Histol. 2005;27:83-94.
166 Sato K, Shimode Y, Hirokawa M, et al. Thyroid adenomatous nodule with bizarre nuclei: a case report and mutation analysis of the p53 gene. Pathol Res Pract. 2008;204:191-195.
167 Casey MB, Sebo TJ, Carney JA. Hyalinizing trabecular adenoma of the thyroid gland: cytologic features in 29 cases. Am J Surg Pathol. 2004;28:859-867.
168 Ryska A, Cap J, Vaclavikova E, et al. Paraganglioma-like medullary thyroid carcinoma: fine needle aspiration cytology features with histological correlation. Cytopathology. 2009;20:188-194.
169 Deligeorgi-Politi H. Nuclear crease as a cytodiagnostic feature of papillary thyroid carcinoma in fine needle aspiration biopsies. Diagn Cytopathol. 1987;3:307-310.
170 Das DK. Intranuclear cytoplasmic inclusions in fine-needle aspiration smears of papillary thyroid carcinoma: a study of its morphological forms, association with nuclear grooves, and mode of formation. Diagn Cytopathol. 2005;32:264-268.
171 Christ ML, Haja JH. Intranuclear cytoplasmic inclusions (invaginations) in thyroid aspirations; frequency and specificity. Acta Cytol. 1979;23:327-331.
172 Gould E, Watzak L, Chamizo W, et al. Nuclear grooves in cytologic preparations. A study of the utility of this feature in the diagnosis of papillary carcinoma. Acta Cytol. 1989;33:16-20.
173 Alkuwari E, Khetani K, Dendukuri N, et al. Quantitative assessment of nuclear grooves in fine needle aspirates of the thyroid: a retrospective cytohistologic study of 94 cases. Analyt Quant Cytol Histol. 2009;31:161-169.
174 Miller JM, Kini SR, Hamburger JI. Needle biopsy of the thyroid: current concepts. New York: Praeger Publishers; 1983.
175 Brooks E, Simmons-Arnold L, Naud S, et al. Multinucleated Giant Cells’ Incidence, Immune Markers, and Significance: A Study of 172 Cases of Papillary Thyroid Carcinoma. Head Neck Pathol. 2009;3:95-99.
176 Suen KC. Altlas and text of aspiration biopsy cytology. London: Williams and Wilkins; 1990.
177 Leung CS, Hartwick RWJ, Berard YC. Correlation of cytologic and histologic features in variants of papillary carcinoma of the thyroid. Acta Cytol. 1993;37:645-650.
178 Das DK, Mallik MK, Haji BE, et al. Psammoma body and its precursors in papillary thyroid carcinoma: a study by fine-needle aspiration cytology. Diagn Cytopathol. 2004;31:380-386.
179 Das DK, Sheikh ZA, George SS, et al. Papillary thyroid carcinoma: evidence for intracytoplasmic formation of precursor substance for calcification and its release from well-preserved neoplastic cells. Diagn Cytopathol. 2008;36:809-812.
180 Shih SR, Li HY, Hsiao YL, et al. Prognostic significance of cytologic features in fine-needle aspiration cytology samples of papillary thyroid carcinoma: preliminary report. Thyroid. 2006;16:775-780.
181 Yip L, Nikiforova MN, Carty SE, et al. Optimizing surgical treatment of papillary thyroid carcinoma associated with BRAF mutation. Surgery. 2009;146:1215-1223.
182 Khurana KK, Truong LD, LiVolsi VA, et al. Cytokeratin 19 immunolocalization in cell block preparation of thyroid aspirates. An adjunct to fine-needle aspiration diagnosis of papillary thyroid carcinoma. Arch Pathol Lab Med. 2003;127:579-583.
183 Bonzanini M, Amadori PL, Sagramoso C, et al. Expression of cytokeratin 19 and protein p63 in fine needle aspiration biopsy of papillary thyroid carcinoma. Acta Cytol. 2008;52:541-548.
184 Sanabria A, Caravalho AL, Piana de Andrade V, et al. Is Galectin-3 a good method for the detection of malignancy in patients with thyroid nodules and a cytologic diagnosis of ‘follicular neoplasm’? A critical appraisal of the evidence. Head Neck. 2007;29:1046-1054.
185 Nga ME, Lim GS, Soh CH, et al. HBME-1 and CK19 are highly discriminatory in the cytological diagnosis of papillary thyroid carcinoma. Diagn Cytopathol. 2008;36:550-556.
186 Harshan M, Crapanzano JP, Aslan DL, et al. Papillary thyroid carcinoma with atypical histiocytoid cells on fine-needle aspiration. Diagn Cytopathol. 2009;37:244-250.
187 Bradly DP, Reddy V, Prinz RA, et al. Incidental papillary carcinoma in patients treated surgically for benign thyroid diseases. Surgery. 2009;146:1099-1104.
188 Khayyata S, Barroeta JE, LiVolsi VA, et al. Papillary hyperplastic nodule: pitfall in the cytopathologic diagnosis of papillary thyroid carcinoma. Endocr Pract. 2008;14:863-868.
189 Baloch ZW, LiVolsi VA. Cytologic and architectural mimics of papillary thyroid carcinoma. Diagnostic challenges in fine-needle aspiration and surgical pathology specimens. Am J Clin Pathol. 2006 Jun;125(Suppl.):S135-S144.
190 Jain M, Khan A, Patwardhan N, et al. Follicular variant of papillary thyroid carcinoma: a comparative study of histopathologic features and cytology results in 141 patients. Endocr Pract. 2001;7:79-84.
191 Aron M, Mallik A, Verma K. Fine needle aspiration cytology of follicular variant of papillary carcinoma of the thyroid: Morphologic pointers to its diagnosis. Acta Cytol. 2006;50:663-668.
192 Wu HH, Jones JN, Grzybicki DM, et al. Sensitive cytologic criteria for the identification of follicular variant of papillary thyroid carcinoma in fine-needle aspiration biopsy. Diagn Cytopathol. 2003;29:262-266.
193 Liu J, Singh B, Tallini G, et al. Follicular variant of papillary thyroid carcinoma: a clinicopathologic study of a problematic entity. Cancer. 2006;107:1255-1264.
194 Fadda G, Fiorino MC, Mule A, et al. Macrofollicular variant of papillary thyroid carcinoma as a potential pitfall in histologic and cytologic diagnosis. A report of three cases. Acta Cytol. 2002;46:555-559.
195 Lugli A, Terracciano LM, Oberholzer M, et al. Macrofollicular variant of papillary carcinoma of the thyroid: a histologic, cytologic, and immunohistochemical study of 3 cases and review of the literature. Arch Pathol Lab Med. 2004;128:54-58.
196 Moreira AL, Waisman J, Cangiarella JF. Aspiration cytology of the oncocytic variant of papillary adenocarcinoma of the thyroid gland. Acta Cytol. 2004;48:137-141.
197 Baloch ZW, LiVolsi VA. Fine-Needle Aspiration Cytology of Papillary Hurthle Cell Carcinoma with Lymphocytic Stroma ‘Warthin-Like Tumor’ of the Thyroid. Endocr Pathol. 1998;9:317-323.
198 D’Antonio A, De Chiara A, Santoro M, et al. Warthin-like tumour of the thyroid gland: RET/PTC expression indicates it is a variant of papillary carcinoma. Histopathology. 2000;36:493-498.
199 Chuah KL, Hwang JSG, Ng SB, et al. Cytologic features of cribriform-morular variant of papillary carcinoma of the thyroid. A case report. Acta Cytol. 2005;49:75-80.
200 Jung CK, Choi YJ, Lee KY, et al. The cytological, clinical, and pathological features of the cribriform-morular variant of papillary thyroid carcinoma and mutation analysis of CTNNB1 and BRAF genes. Thyroid. 2009;19:905-913.
201 Haji BE, Ahmed MS, Prasad A, et al. Papillary thyroid carcinoma with an adenoid cystic pattern: report of a case with fine-needle aspiration cytology and immunocytochemistry. Diagn Cytopathol. 2004;30:418-421.
202 Ustün H, Atalay FO, Ekinci C. Adenoid cystic variant of papillary thyroid carcinoma: a case report with fine-needle aspiration cytology. Diagn Cytopathol. 2008;36:64-66.
203 Leal II, Carneiro FP, Basílio-de-Oliveira CA, et al. Papillary carcinoma with nodular fasciitis-like stroma–a case report in pregnancy. Diagn Cytopathol. 2008;36:139-141.
204 Urano M, Kiriyama Y, Takakuwa Y, et al. Tall cell variant of papillary thyroid carcinoma: Its characteristic features demonstrated by fine-needle aspiration cytology and immunohistochemical study. Diagn Cytopathol. 2009;37:732-737.
205 Ylagan LR, Dehner LP, Huettner PC, et al. Columnar cell variant of papillary thyroid carcinoma. Report of a case with cytologic findings. Acta Cytol. 2004;48:73-77.
206 Jayaram G. Cytology of columnar cell variant of papillary thyroid carcinoma. Diagn Cytopathol. 2000;22:227-229.
207 Lee JY, Shin JH, Han BK, et al. Diffuse sclerosing variant of papillary carcinoma of the thyroid: imaging and cytologic findings. Thyroid. 2007;17:567-573.
208 Nguyen GK, Lee MW. Solid/trabecular variant papillary carcinoma of the thyroid: Report of three cases with fine-needle aspiration. Diagn Cytopathol. 2006;34:712-714.
209 Jayaram G. Trabecular adenoma of the thyroid. Fine needle aspiration cytologic and histologic features in a case. Acta Cytol. 1999;43:978-980.
210 Kuma S, Hirokawa M, Miyauchi A, et al. Cytologic features of hyalinizing trabecular adenoma of the thyroid. Acta Cytol. 2003;47:399-404.
211 Nosé V, Volante M, Papotti M. Hyalinizing trabecular tumor of the thyroid: an update. Endocr Pathol. 2008;19:1-8.
212 Casey MB, Sebo TJ, Carney JA. Hyalinizing trabecular adenoma of the thyroid gland identification through MIB-1 staining of fine-needle aspiration biopsy smears. Am J Clin Pathol. 2004;122:506-510.
213 Kaur A, Jayaram G. Thyroid tumors: cytomorphology of medullary, clinically anaplastic, and miscellaneous thyroid neoplasms. Diagn Cytopathol. 1990;6:383-389.
214 Forrest CH, Frost FA, de Boer WB, et al. Medullary carcinoma of the thyroid. Accuracy of diagnosis by fine-needle aspiration cytology. Cancer (Cancer Cytopathol). 1998;84:295-302.
215 Papaparaskeva K, Nagel H, Droese M. Cytologic diagnosis of medullary carcinoma of the thyroid gland. Diagn Cytopathol. 2000;22:351-358.
216 Moo-Young TA, Traugott AL, Moley JF. Sporadic and familial medullary thyroid carcinoma: state of the art. Surg Clin North Am. 2009;89:1193-1204.
217 Chang TC, Wu SL, Hsiao YL. Medullary carcinoma. Pitfalls in diagnosis by fine needle aspiration cytology and relationship of cytomorphology to RET proto-oncogene mutations. Aca Cytol. 2005;49:477-482.
218 Das DK, Mallik MK, George SS, et al. Secretory activity in medullary thyroid carcinoma: a cytomorphological and immunocytochemical study. Diagn Cytopathol. 2007;35:329-337.
219 Rekhi B, Kane SV, D’Cruz A. Cytomorphology of anaplastic giant cell type of medullary thyroid carcinoma – a diagnostic dilemma in an elderly female: a case report. Diagn Cytopathol. 2008;36:136-138.
219A Duskova J, Janotova D, Svobodova E, et al. Fine needle aspiration biopsy of mixed medullary-follicular thyroid carcinoma: a report of two cases. Acta Cytol. 2003;47:71-77.
220 Marcus JN, Dise CA, LiVolsi VA. Melanin production in a medullary thyroid carcinoma. Cancer. 1982;49:2518-2526.
221 Jayaram G, Hayati JN, Yip CH, et al. Cytologic, histologic and immunocytochemical features in fine needle aspirates of paraganglioma-like variant of medullary carcinoma. Acta Cytol. 2008;52:119-121.
222 Aulicino MR, Szporn AH, Dembitzer R, et al. Cytologic findings in the differential diagnosis of C-cell hyperplasia and medullary carcinoma by fine needle aspiration. A case report. Acta Cytol. 1998;42:963-967.
223 Luze T, Totsch M, Bangerl I, et al. Fine needle aspiration cytodiagnosis of anaplastic carcinoma and malignant haemangioendothelioma of the thyroid in an endemic goitre area. Cytopathol. 1990;6:305-310.
224 Us-Krasovec M, Golouh R, Auersperg M, et al. Anaplastic thyroid carcinoma in fine needle aspirates. Acta Cytol. 1996;40:953-958.
225 Deshpande AH, Munshi MM, Bobhate SJ. Cytological diagnosis of paucicellular variant of anaplastic carcinoma of thyroid: report of two cases. Cytopathol. 2001;12:203-208.
226 Mehdi G, Ansari HA, Siddiqui SA. Cytology of anaplastic giant cell carcinoma of the thyroid with osteoclast-like giant cells–a case report. Diagn Cytopathol. 2007;35:111-112.
227 Cerilli LA, Frable WJ, Spafford MF. Anaplastic carcinoma of the thyroid with chondroblastoma features mimicking papillary carcinoma. A case report. Acta Cytol. 2007;51:825-828.
228 Tani E, Skoog L. Fine needle aspiration cytology and immunocytochemistry in the diagnosis of lymphoid lesions of the thyroid gland. Acta Cytol. 1989;33:48-52.
229 Sangalli G, Serio G, Zampatti C, et al. Fine needle aspiration cytology of primary lymphoma of the thyroid: a report of 17 cases. Cytopathol. 2001;12:257-263.
230 Gupta N, Nijhawan R, Srinivasan R, et al. Fine needle aspiration cytology of primary thyroid lymphoma: a report of ten cases. Cytojournal. 2005;9(2):21.
231 Zhu H, Hu DX. Langerhans cell histiocytosis of the thyroid diagnosed by fine needle aspiration cytology. A case report. Acta Cytol. 2004;48:278-280.
232 Jayaram G, Wong KT, Jalaludin MA. Mucoepidermoid carcinoma of the thyroid: a case report. Malaysian J Pathol. 1998;20:45-48.
233 Das S, Kalyani R. Sclerosing mucoepidermoid carcinoma with eosinophilia of the thyroid. Indian J Pathol Microbiol. 2008;51:34-36.
234 Isa NM, James DT, Saw TH, et al. Primary angiosarcoma of the thyroid gland with recurrence diagnosed by fine needle aspiration: a case report. Diagn Cytopathol. 2009;37:427-432.
235 Poniecka A, Ghorab Z, Arnold D, et al. Kaposi’s sarcoma of the thyroid gland in an HIV-negative woman. A case report. Acta Cytol. 2007;51:421-423.
236 Tong GX, Hamele-Bena D, Liu JC, et al. Fine-needle aspiration biopsy of primary osteosarcoma of the thyroid: report of a case and review of the literature. Diagn Cytopathol. 2008;36:589-594.
237 Majhi U. Primary malignant teratoma of the thyroid in a child with nodal metastases. Indian J Pathol Microbiol. 2009;52:234-236.
238 Jayaram G, Cheah PL, Yip CH. Malignant teratoma of thyroid with predominantly neuroepithelial differentiation-fine needle aspiration cytologic, histologic and immunocytochemical features in a case. Acta Cytol. 2000;44:375-379.
239 Baloch ZW, Sack MJ, Yu GH, et al. Papillary formations in metastatic melanoma. Diagn Cytopathol. 1999;20:148-151.
240 Abati A, Skarulis MC, Shawker T, et al. Ultrasound-guided fine-needle aspiration of parathyroid lesions: a morphological and immunocytochemical approach. Human Pathol. 1995;26:338-343.
241 Layfield LJ. Fine needle aspiration cytology of cystic parathyroid lesions. Acta Cytol. 1991;35:447-450.
242 Glenthoj A, Karstrup S. Parathyroid identification by ultrasonically guided aspiration cytology. Is correct cytological identification possible? APMIS. 1989;97:497-502.
243 Davey DD, Glant MD, Berger EK. Parathyroid cytopathology. Diagn Cytopathol. 1986;2:76-80.
244 Chan SP, Hew FL, Jayaram G, et al. A case report of primary hyperthyroidism with severe bony involvement and nephrolithiasis. Ann Acad Med. 2001;30:66-70.
245 Goellner JR, Caudill JL. Intranuclear holes (cytoplasmic pseudoinclusions) in parathyroid neoplasms, or ‘holes happen. Cancer (Cancer Cytopathol). 2000;90:41-46.













